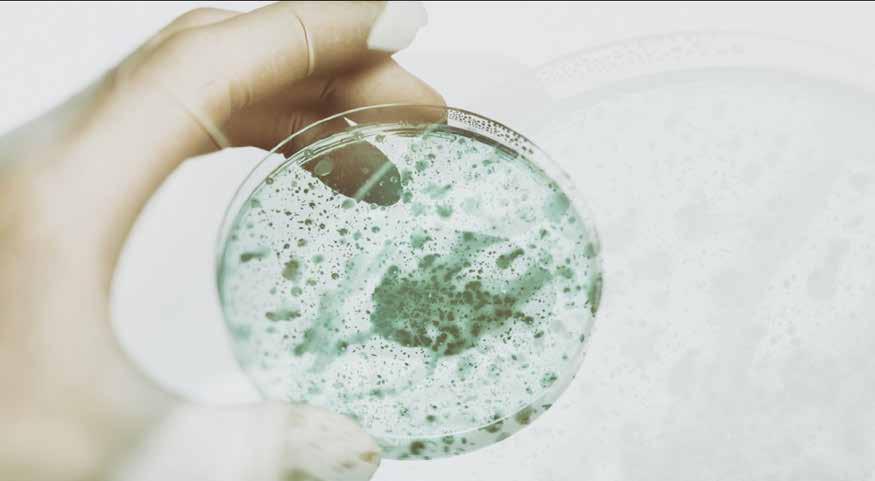

PERSONAL & BUSINESS BANKING
WITH A HOMEFIELD ADVANTAGE

CHECKING | SAVINGS | LENDING









©MyFM Media. This is not a product of a newsroom. MyFM Quest for the Best is operated by MyFM Media. The online platform and contest is provided and powered by Elite Insights. The reproduction by and means of this publication without express permission is prohibited. The use of the unique MyFM Quest for the Best logo is by license only. MyFM Quest for the Best is published as an advertising feature and is distributed by MyFM Media. To be included in future publications or to reach our audience, please contact your sales representative. Visit MyFMMedia.com or call 508-473-1490


We are all winners, right here
“In e Heart of It All”

Welcome to the fourth annual edition of the MyFM Quest for the Best Contest and Magazine! It’s incredible to see how much we’ve grown together in just a few short years.
This year, we’re proud to announce that over 1,600 local businesses were nominated across 252 categories, and we received an astonishing 650,000 votes in just two weeks. This phenomenal response is a testament to our community’s vibrant spirit and unwavering support. In four short years the MyFM Quest for the Best has become the largest “Best Of” contest in the state of Massachusetts!
As we move forward, our focus this year is to continue to position MyFM Media as the cultural hub for all the communities we serve by expanding and improving all of our “Tra-Digital” platforms: on-air, online, mobile apps, print products, video streaming, podcasting, and social media outreach. Our listeners, fans, and followers expect to get what they want, where and when they want it, and we intend to provide it. We believe this direction will not only highlight the best our
community has to offer but also bring us all closer together.
We couldn’t have achieved this success without your enthusiastic participation. Your votes, nominations, and engagement have been the cornerstone of our growth. A special thank you to our sponsors and partners who make this possible.
Looking ahead, we have exciting plans to further enhance the MyFM Quest for the Best experience. Stay tuned, and continue to support your favorite local businesses. Stay connected with us, and don’t hesitate to share your feedback and stories. Thank you for being a part of our journey. Enjoy this edition and celebrate the best of what our community has to offer!
Warm regards,
Tom McAuliffe II President MyFM Media
















PGS 10, 20, 21 & 104
The Whitin Community Center is committed to enhancing the health and well-being of individuals & families and to building a strong community in the Blackstone Valley. We offer social, recreational, educational, and outreach programs that bring community members of all ages and backgrounds together. The WCC is the most complete family & recreation center with two swimming pools, a gym, fitness center, early learning programs, summer camps & more!






Franklin School for the Performing Arts
38 Main St, Franklin fspaonline.com
508-528-8668

Proudly serving more than 500 students from 45 communities, the Franklin School for the Performing Arts is committed to quality arts education with exceptional curriculum, outstanding faculty and unwavering dedication to every student enrolled. FSPA is a unique place where students of all ages and levels of ability participate in an array of music, dance and drama programs with professional instruction and extraordinary performing opportunities.
Duct Tape Wallet
facebook.com/DuctTapeWallet
508-328-5826


Whitin Community Center
60 Main St, Whitinsville WhitinCommunityCenter.com
508-234-8184

Southwick’s Zoo
2 Southwick St, Mendon southwickszoo.com 800-258-9182

Lhe Whitin Community Center is committed to enhancing the health and well-being of individuals and families and to building a strong community in the Blackstone Valley. We offer social, recreational, educational, and outreach programs that bring community members of all ages and backgrounds together. The WCC is the most complete family and recreation center with two swimming pools, a gym, fitness center, early learning programs, summer camps & more!
Goldfish Swim School
350 E Main St, Milford goldfishswimschool.com/milford 508-488-9510

ocated in the beautiful Blackstone Valley minutes from Rte. 495 and 146, Southwick’s Zoo, a favorite destination for over 60 years, offers a full day of fun and adventure! Spanning over 200 acres, it is New England’s largest zoo; home to over 850 animals in naturalistic habitats, 35-acre deer forest, petting zoo, exciting rides and so much more! A unique and perfect venue for weddings, corporate outings, birthday parties and other private events.
Bernat Antiques
89 Elmdale Rd, Uxbridge facebook.com/bernatantique 508-278-5525


Blackstone Valley Art Association
5 N Main St, Uxbridge 774-287-1288
Since its inception in 1957, the Blackstone Valley Art Association has been dedicated to the advancement of the arts and preservation of the finest artistic traditions by means of exhibitions, classes, lectures, and other activities favorable to artistic expression, and to the development of friendly exchanges amongst artists and those interested in the arts.


Hopkinton Center For The Arts
98 Hayden Rowe St, Hopkinton hopartscenter.org 508-435-9222








Sparetime Recreation
117 Church St, Northbridge bowlsparetime.com
508-266-0699

We are very excited with the updates that have been happening over the past several months! We now have an adult area that can enjoy new games and pool tables with an updated menu for beer and wine! We’ve added some more games to our arcade area and a 15-person bar area to enjoy a great beer and wine selection. Strike up conversations and socialize while bowling our 12 lane candlepin alley and enjoy great food from the Neighborhood Kitchen too!
Ryan Family Amusements
1170 Main St, Millis ryanfamily.com
508-376-1101


Southwick’s Zoo
2 Southwick St, Mendon southwickszoo.com
800-258-9182

Milford Regional Medical Center
14 Prospect St, Milford milfordregional.org
508-473-1190

Milford Regional Medical Center, Inc. is a non-profit healthcare system that includes the Medical Center, Milford Regional Physician Group and Milford Regional Healthcare Foundation. Located at the intersection of Rts. 40 and 16 in Milford, MA, Milford Regional serves residents of 20plus towns as a 149-bed, full-service, acute-care, community and regional teaching hospital with over 300 primary care and specialty physicians on our medical staff.
CraftRoots Brewing
4 Industrial Rd, Milford craftrootsbrewing.com
508-381-1920


ocated in the beautiful Blackstone Valley minutes from Rte. 495 and 146, Southwick’s Zoo, a favorite destination for over 60 years, offers a full day of fun and adventure! Spanning over 200 acres, it is New England’s largest zoo; home to over 850 animals in naturalistic habitats, 35-acre deer forest, petting zoo, exciting rides and so much more! A unique and perfect venue for weddings, corporate outings, birthday parties and other private events.
Family Karate Center
96 Church St, Whitinsville familykaratecenter.net
508-234-0900


THE BLACK BOX
15 W Central St, Franklin THEBLACKBOXonline.com
508-528-3370

THE BLACK BOX is a versatile theater and event venue in downtown Franklin, Massachusetts. With its captivating theatrical productions, riveting live music performances, and a wide array of special events, THE BLACK BOX is ideal for those seeking immersive and remarkable entertainment experiences. THE BLACK BOX proudly serves as the home of the Franklin Performing Arts Company, MetroWest’s only Equity professional theater.
Gillette Stadium
1 Patriot Pl, Foxborough gillettestadium.com
508-543-8200




Franklin School for the Performing Arts
38 Main St, Franklin fspaonline.com
508-528-8668

Proudly serving more than 500 students from 45 communities, the Franklin School for the Performing Arts is committed to quality arts education with exceptional curriculum, outstanding faculty and unwavering dedication to every student enrolled. FSPA is a unique place where students of all ages and levels of ability participate in an array of music, dance and drama programs with professional instruction and extraordinary performing opportunities.
Mckeon Dance & Gymnastics
3A Spaceway Ln, Hopedale mckeondanceandgym.com
508-473-8166


PiNZ Bowl
110 S Main St, Milford pinzbowl.com
508-473-6611

Southwick’s Zoo
2 Southwick St, Mendon southwickszoo.com
800-258-9182

Lhe one-stop entertainment destination for all ages featuring bowling, arcade games, axe throwing, virtual reality and laser tag, plus a menu full of tasty American classics and hand-crafted drinks.
Putts & More Family Fun Center
750 Concord St, Holliston puttsandmore.com
508-561-2902

ocated in the beautiful Blackstone Valley minutes from Rte. 495 and 146, Southwick’s Zoo, a favorite destination for over 60 years, offers a full day of fun and adventure! Spanning over 200 acres, it is New England’s largest zoo; home to over 850 animals in naturalistic habitats, 35-acre deer forest, petting zoo, exciting rides and so much more! A unique and perfect venue for weddings, corporate outings, birthday parties and other private events.
Putts & More Family Fun Center
750 Concord St, Holliston puttsandmore.com
508-561-2902


Shining Rock Golf Club
91 Clubhouse Ln, Northbridge shiningrock.com
508-234-0400


Voted one of the Top 10 Public Courses in Massachusetts, Shining Rock is New England’s premier 27-hole golf destination, known for its stellar practice facilities, fantastic clubhouse menu, breathtaking natural beauty and topnotch service. With views of the Blackstone Valley, this is sure to be one of your favorite courses in Massachusetts.
Blackstone National Golf Club
227 Putnam Hill Rd, Sutton bngc.net
508-865-2111


New England Cheer and Tumble Training Center
89 Hartford Ave E, Mendon necheerandtumble.com 774-219-4474

New England Cheer and Tumble Training Center, LLC is a gym designed for instructional classes specific to cheer and tumble, focusing on the importance of perfection before progression. NE Cheer and Tumble offers classes for athletes to strengthen and sharpen skills for this incredibly difficult sport. Strength training and proper technique practices are the best ways to keep our athletes safe from injuries.
The Little Gym of Medway
74 Main St, Medway thelittlegym.com/massachusetts-medway 508-533-9405


The Claflin Hill Symphony Orchestra
208 Main St, Milford claflinhill.org 508-478-5924

Claflin Hill brings the power of its amazing orchestra and musicians- together with our cultural partners in the community— to present what has become our region’s signature holiday experience to herald in the holiday season. We showcase traditional Christmas sing-alongs, Hanukkah tunes, featured soloists and more. Santa Claus stops by, walking through the audience, greeting the young and the young at heart. There’s always something new, too.
Southwick’s Zoo
2 Southwick St, Mendon southwickszoo.com 800-258-9182









Doubletree Hotel Boston Milford
11 Beaver St, Milford hilton.com
508-478-7010

The DoubleTree Milford is the only full service hotel in Milford! Stay for a night in our comfortable rooms. Join us in Legends for a great meal and your favorite beverage, and enjoy our full breakfast buffet in the morning. In the summer, check out the new Oasis Patio for food and entertainment. Celebrating a special occasion in life? Let us host your wedding, Bat Mitzvah, or your bridal/baby shower in our 10,000 sq ft of banquet space.
Fairfield Inn & Suites Boston Milford
1 Fortune Blvd, Milford marriott.com
508-478-0900


Legends Sports Bar & Grille @ DoubleTree Milford
11 Beaver St, Milford BostonMilford.DoubleTree.com
508-478-7010

LThe Claflin Hill Symphony Orchestra
208 Main St, Milford claflinhill.org
508-478-5924

Cegends Sports Bar & Grille in the DoubleTree Milford features All-American pub food, and a focus on local draft beers and signature cocktails. Come on down to catch your favorite Boston sports teams, a trivia night, or live entertainment on the weekends.
THE BLACK BOX
15 W Central St, Franklin THEBLACKBOXonline.com
508-528-3370

laflin Hill proudly celebrates its 25th anniversary season as a vibrant, world-class cultural center for the entire community. Hosting full symphony concerts at the historic Grand Ballroom of the Milford Town Hall, as well as chamber music and jazz performances, and over a dozen outdoor summer park concerts throughout the region, Claflin Hill masterfully recreates an aura in our concert halls reminiscent of the golden days of live music.
Duct Tape Wallet
facebook.com/DuctTapeWallet
508-328-5826


AdviniaCare Northbridge
85 Beaumont Dr, Northbridge adviniacare.com
508-234-9771


For the very best in assisted living, memory care, skilled nursing and respite stay, AdviniaCare Northbridge is here for you and your family. As you drive up the hill you will see our beautiful property, where we are proud to provide a unique living experience in a historical mansion. Our exceptional team is dedicated to providing a safe and vibrant community that feels just like home to all who walk through our doors.
Salmon Senior Living: The Willows and Whitney Place at Medway Multiple Locations salmonhealth.com
508-657-6700


Duct Tape Wallet
facebook.com/DuctTapeWallet
508-328-5826
Duct Tape Wallet is a collaboration of longtime friends who have melted their musical influences into a fun-loving sound of funk, blues and rock. Their original songs have just as much zest as the unique cover songs that are played. DTW always brings great energy to every show!


Accent Limousine
48 Pond St, Milford accentlimo.com
508-473-2262
SCarolyn Rae & The Rumors facebook.com/carolynrae.therumors
508-272-1224




ince 1985, this family-owned business has spent the last 35+ years perfecting luxury transportation. Their diverse fleet can accommodate a single rider, a family (including the dog), or all your friends and coworkers. They service Boston, Worcester, Providence, and the greater MyFM listening area. Make your reservation with Accent, and let them show you the Accent experience! They guarantee satisfaction... as you can see by their gold medal!
Knights Airport Limousine Services
390 Hartford Turnpike, Shrewsbury knightslimo.com
508-839-6252

New England Cheer and Tumble Training Center, LLC is a gym designed for instructional classes specific to cheer and tumble, focusing on the importance of perfection before progression. NE Cheer and Tumble offers classes for athletes to strengthen and sharpen skills for this incredibly difficult sport. Strength training and proper technique practices are the best ways to keep our athletes safe from injuries.





Little Critters Daycare & Preschool
96 Medway Rd, Milford
littlecrittersdaycare.com
508-381-3725

We offer programs for infants, toddlers and preschool children. Each program is designed for both fun and education with structured schedules that provide a variety of activities, lunch, rest time, indoor and outdoor times. Each program has weekly themes that incorporate learning through play and hands on activities. We also have a tumble bus Fridays as well. We believe children learn best through hands on experiences and modeling.
Whitin Community Center
60 Main St, Whitinsville WhitinCommunityCenter.com
508-234-8184


Little Critters Daycare & Preschool
96 Medway Rd, Milford
littlecrittersdaycare.com
508-381-3725
W

e offer programs for infants, toddlers and preschool children. Each program is designed for both fun and education with structured schedules that provide a variety of activities, lunch, rest time, indoor and outdoor times. Each program has weekly themes that incorporate learning through play and hands on activities. We also have a tumble bus Fridays as well. We believe children learn best through hands on experiences and modeling.
Franklin School for the Performing Arts
38 Main St, Franklin fspaonline.com
508-528-8668


Dean College
99 Main St, Franklin dean.edu
508-541-1900

Dean College is a private, residential New England college grounded in a culture and tradition that all students deserve the opportunity to discover and exceed their greatest aspirations. A personal and transformative community since 1865, Dean tirelessly inspires our students to unimagined heights through personalized support and integrated delivery of academic, co-curricular and experiential learning.
Framingham State University
100 State St, Framingham framingham.edu
508-620-1220


Little Critters Daycare & Preschool
96 Medway Rd, Milford
littlecrittersdaycare.com
508-381-3725
W

e offer programs for infants, toddlers and preschool children. Each program is designed for both fun and education with structured schedules that provide a variety of activities, lunch, rest time, indoor and outdoor times. Each program has weekly themes that incorporate learning through play and hands on activities. We also have a tumble bus Fridays as well. We believe children learn best through hands on experiences and modeling.
Whitin Community Center
60 Main St, Whitinsville WhitinCommunityCenter.com
508-234-8184


Whitin Community Center
60 Main St, Whitinsville WhitinCommunityCenter.com
508-234-8184

The Whitin Community Center is committed to enhancing the health and well-being of individuals and families and to building a strong community in the Blackstone Valley. We offer social, recreational, educational, and outreach programs that bring community members of all ages and backgrounds together. The WCC is the most complete family and recreation center with two swimming pools, a gym, fitness center, early learning programs, summer camps & more!
Creative Community Childcare
23 Pine St, Milford


Tri-County Regional Vocational Technical High School
147 Pond St, Franklin tri-county.us 508-528-5400
Our mission is to provide an excellent comprehensive technical and academic education to regional high school students. State-of-the-art technical skills and knowledge are enriched and complemented by a solid foundation of academic skills. Creative and cooperative partnerships between area employers and a dynamic staff guarantee the continued growth and development of exciting programs designed to prepare graduates for their careers.
Blackstone Valley Vocational

65 Pleasant St, Upton valleytech.k12.ma.us 508-529-7758

Known for our innovation, this forward-thinking region focuses on the future while treasuring the best of our New England past. The intersection of the oldest and newest, MetroWest Boston o ers the best of both worlds, just a 20- to 40-minute drive from Boston or Worcester. With major arteries crisscrossing our region, you’re never far from what you like: recreation in all seasons, sophisticated amenities and services, upscale shopping and dining, a range of cultural attractions, and traditional New England town commons.








We offer programs for infants, toddlers, and preschool. Each classroom is designed for both fun and education with structured schedules that provide a variety of activities; lunch, rest time and indoor/outdoor play times. We are open Monday thru Friday 7 am to 5:30 pm. We offer 3 days, 4 days and fulltime spots for all our programs.










Established in 1977, Tri-County’s mission is to provide an excellent comprehensive technical and academic education to regional high school students. State-of-the-art technical skills and knowledge are enriched and complemented by a solid foundation of academic skills. This is a place where students succeed and are well-prepared for work or college. 147 Pond Street Franklin, MA 02038 508-528-5400 www.tri-county.us












Voted Best Trade/Technical School



























Known for its fresh sushi, flavorful stir-fries, and aromatic curries, the restaurant uses only the highest quality ingredients. With elegant decor and a warm ambiance, Southside Asian Cuisine is the perfect setting for both casual meals and special occasions. The attentive and friendly staff at Southside Asian Cuisine ensure a pleasant dining experience for all guests. Additionally, the restaurant features a selection of signature cocktails and imported teas, enhancing the overall culinary journey. The restaurant also offers convenient takeout and delivery options for those who prefer to enjoy their meals at home. With rave reviews from both locals and visitors, Southside Asian Cuisine has become a beloved staple in the community. Whether you’re a regular or a first-time visitor, Southside Asian Cuisine promises a memorable dining experience every time.

Elizabeth’s Bagels & More
456 W Central St, Franklin elizabethsbagels.com
508-541-3988

Elizabeth’s Bagels & More has been a Franklin gathering place since 1995. Our bagels are made from scratch, kettle boiled the old-fashioned way and have no added preservatives. Open 6 a.m. - 2 p.m. or until bagels run out! Get in early. Get in fast. Get ‘em while they last!

Blooming Hearts Roastery & Café
206 E Main St, Milford bloomingheartsroastery.com
All of our coffee is ethically sourced and roasted in house. Immerse yourself in the aroma of freshly roasted beans as we handcraft your perfect cup of coffee, ensuring each sip ignites your senses. Indulge in our delectable empanadas and other baked goods. Sit and enjoy some light reading or play a game with friends. Join us and experience the essence of community, passion, and exceptional flavors that define our unique roastery and café.

Muffin House Cafe
116 Main St, Medway muffinhousecafe.com
508-533-6655


Doubletree Hotel Boston Milford
11 Beaver St, Milford hilton.com
508-478-7010

The DoubleTree Milford is the only full service hotel in Milford! Stay for a night in our comfortable rooms. Join us in Legends for a great meal and your favorite beverage, and enjoy our full breakfast buffet in the morning. In the summer, check out the new Oasis Patio for food and entertainment. Celebrating a special occasion in life? Let us host your wedding, Bat Mitzvah, or your bridal/baby shower in our 10,000 sq ft of banquet space.
Restaurant 45
45 Milford St, Medway
508-533-8171

The Donut Stand
154 Turnpike Rd, Southborough thedonutstand.com
508-625-1083


PJ’s Bar & Grill
191 Mechanic St, Bellingham facebook.com/PjBarGrill 508-657-1787

PJ’s is the go-to sports bar in Bellingham! With a vast selection of bar food to choose from, including our famous homemade mac & cheese bowls and customizable burgers, PJ’s is the perfect spot to catch the game with friends. With 14 unique wing sauces to try, you’ll never run out of options for your next visit. Come on over to PJ’s and experience the ultimate sports bar atmosphere!
Legends Sports Bar & Grille @ DoubleTree Milford
11 Beaver St, Milford BostonMilford.DoubleTree.com 508-478-7010







































Goodstuff Smokehouse
97 Main St, Blackstone goodstuffsmokehouse.com
508-928-1815

With one foot firmly planted in the traditions of the South, combined with rich New England hickory and premium meats, Goodstuff Smokehouse is bringing respect to New England Style BBQ. Come on in and have a brewski from one of our ever-changing list of 18 frosty cold drafts, or perhaps a whiskey from our house barrel or growing list (over 125) while you read about tasting notes for each selection in our “Whiskey Bible.” 97 Main St., Blackstone, MA
Paradise BBQ and Catering facebook.com/ScottMoran43
508-254-7214

Goodstuff Smokehouse
97 Main St, Blackstone goodstuffsmokehouse.com
508-928-1815


WThe Spoon
1 Lumber St, Hopkinton
thespoondiners.com
774-803-7125

The Spoon is a woman owned, family run restaurant. We are a fun, relaxed environment to enjoy breakfast or lunch. Join us on our new patio space and don’t forget about our ice cream shop, The Spoonery, for a sweet treat!
Blooming Hearts Roastery & Cafe
206 E Main St, Milford bloomingheartsroastery.com


ith one foot firmly planted in the traditions of the South, combined with rich New England hickory and premium meats, Goodstuff Smokehouse is bringing respect to New England Style BBQ. Come on in and have a brewski from one of our ever-changing list of 18 frosty cold drafts, or perhaps a whiskey from our house barrel or growing list (over 125) while you read about tasting notes for each selection in our “Whiskey Bible.” 97 Main St., Blackstone, MA
Depot Street Tavern
45 Depot St, Milford depotsttavern.com
508-488-6844


CraftRoots Brewing
4 Industrial Rd, Milford
craftrootsbrewing.com
508-381-1920

CraftRoots is a truly local brewery and taproom with a neighborhood vibe that’s genuine and welcoming. A staple since its opening in Milford in 2017, CraftRoots has become known for super-fresh beer, local live music, a spacious + sunny outdoor beer garden, friendly service. Family-owned and operated, it’s the first 100% women-owned brewery in MA. Brewer Maureen Fabry crafts each beer herself exclusively with local craft malt. 8 beers on draft.
Start Line Brewing Co
151R Hayden Rowe St, Hopkinton startlinebrewing.com
508-258-7200


The Spoon
1 Lumber St, Hopkinton thespoondiners.com 774-803-7125

The Spoon is a woman owned, family run restaurant. We are a fun, relaxed environment to enjoy breakfast or lunch. Join us on our new patio space and don’t forget about our ice cream shop, The Spoonery, for a sweet treat!

Doubletree Hotel Boston Milford
11 Beaver St, Milford hilton.com
508-478-7010















King Street Cafe
390 King St, Franklin kingstreetcafe.com
508-541-7117

Agreat day starts with a great breakfast at King Street Cafe. We treat breakfast with the pomp and ceremony it deserves, using farm-fresh ingredients to craft food you’ll spend the next six days dreaming about. Come check us out, you won’t be disappointed. We are located in Franklin, off Route 495, at the King Street Exit 41.
Legends Sports Bar & Grille @ DoubleTree Milford 11 Beaver St, Milford BostonMilford.DoubleTree.com
508-478-7010




























Galliford’s Restaurant & Tavern
2 Southwick St, Mendon gallifords.com
508-928-0928
Located at Southwick’s Zoo, Galliford’s

Restaurant & Tavern brings upscale New England fare in a cozy rustic setting to Mendon, Massachusetts. Boasting beautiful views, a cozy atmosphere and farm fresh ingredients, Galliford’s delivers a great family experience. We are the perfect venue for a variety of events including weddings, showers, corporate outings and more. Our knowledgeable and friendly staff are here to help you from start to finish.
King Street Cafe
390 King St, Franklin kingstreetcafe.com
508-541-7117


Dairy Queen Grill & Chill of Bellingham
21 N Main St, Bellingham
dairyqueen.com/en-us/locations/ma/ bellingham/21-n-main-st/139 508-966-0461
T

Oliva’s Market & Catering
85 E Main St, Milford olivasmarket.com
508-473-7920

Ohe Dairy Queen Grill & Chill of Bellingham, MA has been owned by the same family for 50 years out of the 56 years in business at the same location. We love that we have been able to serve the best quality fast food and legendary soft-serve treats. We would like to thank all of our fans for their loyal support over the years. Here’s to the next 56 years of “Happy tastes good!”
Dairy Queen Grill & Chill Milford
190 W St, Milford
dairyqueen.com/en-us/locations/ma/milford/190-west-st/165/ 508-473-4654


liva’s is a family owned and operated Italian market, deli, catering business, and gift shop that has been serving the Greater Milford area for over 60 years. We provide a variety of homemade Italian foods and baked goods including porketta, sandwiches, calzones, pizza, homemade Italian sausage, and a variety of desserts. Our catering menu makes planning your next party stress-free and our gift shop boasts unique gift ideas for every occasion.
Goodstuff Smokehouse
97 Main St, Blackstone goodstuffsmokehouse.com
508-928-1815


Goodstuff Smokehouse
97 Main St, Blackstone goodstuffsmokehouse.com 508-928-1815

With one foot firmly planted in the traditions of the South, combined with rich New England hickory and premium meats, Goodstuff Smokehouse is bringing respect to New England Style BBQ. Come on in and have a brewski from one of our ever-changing list of 18 frosty cold drafts, or perhaps a whiskey from our house barrel or growing list (over 125) while you read about tasting notes for each selection in our “Whiskey Bible.” 97 Main St., Blackstone, MA
PJ’s Smoke ‘N’ Grill
112B Main St, Medway pjsmedway.com 508-321-1193



Candy Under Cover 2
CandyUnderCover2.com
508-284-3953

If you are looking for party favors, dessert platters or candy buffet additions— look no further! We put a twist on America’s favorite snacks and drench them in creamy milk or white chocolate and top them with colorful candy decorations. If you love Oreo cookies, rice krispy treats, pretzels, etc. call us to create a masterpiece party favor or dessert that will be show stoppers. Call us today to book your event!
Pandolfi’s Fine Chocolates
40 N Main St, Bellingham pandolfischocolates.com
508-966-9840


New England Steak & Seafood
11 Uxbridge Rd, Mendon nesteakandseafood.com
508-473-5079

Pirate’s Cove
74 Providence Rd, Whitinsville piratescovema.com
508-234-0700

We are a restaurant located in Northbridge, MA specializing in fried seafood, tacos, chicken, burgers, hot dogs, ice cream and many other items. Stop by to try some of our delicious hand battered Gloucester style seafood, a Giffords Ice Cream or one of our 30 flavors of soft serve ice cream. Come see why locals have loved us since 1996!
Galliford’s Restaurant & Tavern
2 Southwick St, Mendon gallifords.com
508-928-0928
COFFEE HOUSE

ew England Steak and Seafood has been owned and operated by the Quirk family since 1956. For over 50 years, we have been providing the area with unsurpassed excellence in casual dining, in a quaint Old New England atmosphere.
Oasis Patio @ Doubletree Boston-Milford
11 Beaver St, Milford BostonMilford.DoubleTree.com
508-478-7010


Blooming Hearts Roastery & Café
206 E Main St, Milford bloomingheartsroastery.com
All of our coffee is ethically sourced and roasted in house. Immerse yourself in the aroma of freshly roasted beans as we handcraft your perfect cup of coffee, ensuring each sip ignites your senses. Indulge in our delectable empanadas and other baked goods. Sit and enjoy some light reading or play a game with friends. Join us and experience the essence of community, passion, and exceptional flavors that define our unique roastery and café.


Muffin House Cafe
116 Main St, Medway muffinhousecafe.com
508-533-6655


The Curry House
418 W Central St, Franklin thecurryhouse.com
508-520-2900

Serving fine Indian food for over 9 years in Franklin, MA. The Curry House offers lunch buffet 7 days a week and cozy dining room service outfitted with white table cloths for dinner. There is also full bar service. The Curry House has a drive-through window where your orders can be called in or ordered online at www.thecurryhouse.com. We offer off-property catering available for corporate and special events.
Sol de Mexico
Multiple Locations soldemexicorestaurants.com
508-966-4000


Wright’s Dairy Farm and Bakery
200 Woonsocket Hill Rd, North Smithfield wrightsdairyfarm.com 401-767-3014

As one of the leading fresh local bakeries in the area, it has always been our goal to serve fresh, delicious pastries with friendly, courteous service. We specialize in a number of baked goods, including dessert cakes, cupcakes, cream pastries, flaky pastries, pies, bars, sweet rolls and buns, assorted cookies and more. Our bakery is renowned for using only the highest quality ingredients, producing the best tasting baked goods in the area.
Muffin House Cafe
116 Main St, Medway muffinhousecafe.com
508-533-6655








Restaurant 89
89 Main St, Milford restaurant89.com
508-634-8911

Elegant Modern Meals In A Comfortable Setting. Elegant modern meals in a comfortable setting. Restaurant 89 is Milford’s home for traditional and modern Italian dining and cocktails. Set in the historic Thom Building, our restaurant consists of a beautiful dining area and a nearly 1,000 sq ft function area complete with our private Captain’s Table area. Contact us today with any questions!
Galliford’s Restaurant & Tavern
2 Southwick St, Mendon gallifords.com
508-928-0928


C&C Ice Cream Truck cncicecreamtruck.com
508-265-7846
C &C Ice Cream Truck specializes in parties and corporate events of all kind and sizes. We are a family-owned business out of Norfolk, Massachusetts, and our family ensures a special one-of-a kind experience. Show your staff that you appreciate them, have the coolest party, the best late night wedding snack, school or scouting event, fundraiser or anything in between. Find us on Facebook, cncicecreamtruck.com, or email cncicecreamtruck@gmail.com.
Dairy Queen Grill & Chill of Bellingham
21 N Main St, Bellingham dairyqueen.com/en-us/locations/ma/bellingham/21-n-main-st/139 508-966-0461

Dacey’s Market & Deli
353 Lincoln St, Franklin daceysmarket.com
508-528-1988

Dacey’s Market is a one-stop shop for all your grocery needs! We offer an extensive selection of Boar’s Head Deli Meats, fresh quality meats, deli items, prepared food, and convenience items. We also offer a high end variety of wines, craft beers and spirits. Check out our selection of everyday items today and save yourself a trip to the supermarket!
Oliva’s Market & Catering
85 E Main St, Milford olivasmarket.com
508-473-7920



The Donut Stand
154 Turnpike Rd, Southborough thedonutstand.com
508-625-1083
D


onut Stand donuts are made using a fresh yeast raised brioche dough that is built over 24 hours to allow a slow fermentation resulting in a better quality donut. They also make old fashioned buttermilk donuts. The donuts are hand rolled, cut, and fried fresh. New menu items and flavors are always being introduced to give customers a fresh experience and showcase what the seasons and chefs have to offer.
Basic Batch Donuts
206 E Main St, Milford basicbatchdonuts.com


Fairmount Fruit Farm Inc
885 Lincoln St, Franklin fairmountfruit.com
508-533-8737

We are a small family farm that’s over 100 years old with an orchard, greenhouses, and hydroponics as well as an assortment of farm animals. We have a variety of fun events including our farmer’s markets and kids programs, where you can experience the beauty of the farm up close! Plus, book our greenhouse for a birthday party, tea party, baby shower or romantic date night. We can’t wait to see you here.
Tangerini Farms
139 Spring St, Millis tangerinisfarm.com
508-376-5024


Fairmount Fruit Farm Inc
885 Lincoln St, Franklin fairmountfruit.com
508-533-8737

We are a small family farm that’s over 100 years old with an orchard, greenhouses, and hydroponics as well as an assortment of farm animals. We have a variety of fun events including our farmer’s markets and kids programs, where you can experience the beauty of the farm up close! Plus, book our greenhouse for a birthday party, tea party, baby shower or romantic date night. We can’t wait to see you here.
Out Post Farm
300 Prentice St, Holliston outpostfarmma.com
508-429-5244




Dairy Queen Grill & Chill of Bellingham
21 N Main St, Bellingham dairyqueen.com/en-us/locations/ma/ bellingham/21-n-main-st/139 508-966-0461

We love that we have been serving the Bellingham community since 1966! For the past 56 years, the Bellingham, MA, DQ Grill & Chill has served the best quality fast food and legendary soft-serve treats. We would like to thank all of our fans for their loyal support over the years. Here’s to the next 56 years of “Happy tastes good!”
Dairy Queen Grill & Chill Milford
190 West St, Milford dairyqueen.com/en-us/locations/ma/milford/190-west-st/165/ 508-473-4654


Pirate’s Cove
74 Providence Rd, Whitinsville piratescovema.com
508-234-0700
W

e are a restaurant located in Northbridge, MA specializing in fried seafood, tacos, chicken, burgers, hot dogs, ice cream and many other items. Stop by to try some of our delicious hand battered Gloucester style seafood, a Giffords Ice Cream or one of our 30 flavors of soft serve ice cream. Come see why locals have loved us since 1996!

New England Steak & Seafood
11 Uxbridge Rd, Mendon nesteakandseafood.com
508-473-5079
NNelly’s Sandwich Shop
113 Central St, Milford
nellysmilford.com
508-634-8144

ew England Steak and Seafood has been owned and operated by the Quirk family since 1956. For over 50 years, we have been providing the area with unsurpassed excellence in casual dining, in a quaint Old New England atmosphere.
Restaurant 89
89 Main St, Milford restaurant89.com
508-634-8911


Blooming Hearts Roastery & Café
206 E Main St, Milford bloomingheartsroastery.com
All of our coffee is ethically sourced and roasted in house. Immerse yourself in the aroma of freshly roasted beans as we handcraft your perfect cup of coffee, ensuring each sip ignites your senses. Indulge in our delectable empanadas and other baked goods. Sit and enjoy some light reading or play a game with friends. Join us and experience the essence of community, passion, and exceptional flavors that define our unique roastery and café.


The Spoon
1 Lumber St, Hopkinton thespoondiners.com
774-803-7125


















Paradise BBQ and Catering facebook.com/ScottMoran43
508-254-7214
Paradise BBQ started in the fall of 2020. We do private/corporate events as well as serve local venues. In just our third year, we graduated to an 18’ food trailer. We advertise by Facebook, Instagram and by word of mouth. Currently, my wife Ellen and I work full time jobs and do BBQ on the weekends. With gold and a silver in this year’s competition, we will be going full time and be able to expand our horizons.
Larry Joe’s New England Firepit
89 Hartford Ave E, Mendon larryjoesfirepit.com
508-735-9006


C&C
cncicecreamtruck.com
508-265-7846
C&C Ice Cream Truck specializes in parties and corporate events of all kind and sizes. We are a family-owned business out of Norfolk, Massachusetts, and our family ensures a special one-of-a kind experience. Show your staff that you appreciate them, have the coolest party, the best late night wedding snack, school or scouting event, fundraiser or anything in between. Find us on Facebook, cncicecreamtruck.com, or email cncicecreamtruck@gmail.com.



Ichigo Ichie
837 W Central St, Franklin ichigoichieus.com
508-541-8881

Ichigo Ichie stands for “one chance, one encounter” and is the kind of hospitality we strive to achieve. At Ichigo Ichie, one can find traditional Japanese cuisine as well as modern influence in perfect harmony. Whether it be casual dining or that special occasion, Ichigo Ichie is just the right place for you. Choose to sit at the bar or lounge for a casual night or stay in our dining room for a more private ambiance.
121 Depot St, Milford
Find us on Facebook
508-478-7788

Pirate’s Cove
74 Providence Rd, Whitinsville piratescovema.com
508-234-0700


Larry Joe’s New England Firepit
89 Hartford Ave E, Mendon larryjoesfirepit.com
508-735-9006

Larry Joe’s New England Firepit is recognized by the Phantom Gourmet and People Magazine as having some of the best hot dogs in all New England. Visit Larry Joe’s, a roadside treasure for a bit of music, great talk, and a story to tell later. Not only that, but you’ll have two great choices of hot dogs to choose from and one of the best pastrami sandwiches anywhere. Add Larry Joe’s famous toppings to complete this roadside experience!
Snappy Dogs
61 Main St, Hopkinton
Find us on Facebook 617-383-7627


Mickey Cassidy’s
116 Main St, Medway
MickeyCassidys.com
508-533-1343

Mickey Cassidy’s is a family owned gastropub in Medway. We have been in business for over 20 years. Recently, Mickey passed the business to his daughter, Kate, who has revamped the restaurant and its menu with Chef
Laura McDaniel. We offer creative cocktails, a large beer selection, and delicious homemade food. Our staff is one of a kind— always smiling and working hard to provide the best service. Come on in and see us; you’ll be glad you did!
Cornell’s Irish Pub
229 Hayden Rowe St, Hopkinton cornellsirishpub.com
508-435-6192



The Rome Restaurant
4 E Central St, Franklin the-rome.com
508-528-4740


Established in 1965 by Eugenio and Filomena Colace. As the family enters its 2nd generation, The Colace Brothers are proud to carry on the tradition of serving delicious homemade Italian cuisine at an affordable price. All of our soups, sauces, entrees and pizzas are made fresh in our kitchen daily. We take pride in making our homestyle Italian cooking to be


1A Nipmuc Dr Mendon, MA 01756 508-381-0068


















Ichigo Ichie
837 W Central St, Franklin ichigoichieus.com
508-541-8881

Ichigo Ichie stands for “one chance, one encounter” and is the kind of hospitality we strive to achieve. At Ichigo Ichie, one can find traditional Japanese cuisine as well as modern influence in perfect harmony. Whether it be casual dining or that special occasion, Ichigo Ichie is just the right place for you. Choose to sit at the bar or lounge for a casual night or stay in our dining room for a more private ambiance.
Tokyo Japanese Steak House
121 Depot St, Milford
Find us on Facebook 508-478-7788


Pirate’s Cove
74 Providence Rd, Whitinsville piratescovema.com
508-234-0700

We are a restaurant located in Northbridge, MA specializing in fried seafood, tacos, chicken, burgers, hot dogs, ice cream and many other items. Stop by to try some of our delicious hand battered Gloucester style seafood, a Giffords Ice Cream or one of our 30 flavors of soft serve ice cream. Come see why locals have loved us since 1996!

Nutriforia Nutrition
91 Medway Rd, Milford facebook.com/nutriforianutrition 774-209-2136
ORosewood Restaurant
445 Hartford Ave, Bellingham rosewoodbellingham.com
508-966-1126

ffering the community a healthier option to traditional drive through meals. Serving the best nutrient dense, low calorie meal replacement shakes and energizing, metabolism boosting teas in the area!
Crossroads Nutrition
155 Main St, Grafton Goherbalife.com/samanthacarrion 774-293-5222


Sol de Mexico
Multiple Locations soldemexicorestaurants.com 508-966-4000


Family-owned restaurant, striving to provide a unique experience to each and every one of our customers. Offering a variety of dishes from different regions of Mexico along with specially crafted cocktails and margaritas with the best tequilas around! This community is like our second family, and our goal is to continue satisfying them each and every day. We do it all, dine-in, take out, specials, catering, parties, and even live entertainment!
Acapulcos Mexican Family Restaurant & Cantina Milford
Multiple Locations acapulcos.net
508-478-7197















Ichigo Ichie stands for one chance, one encounter, and is the kind of hospitality we strive to achieve. At Ichigo Ichie, one can find traditional Japanese cuisine as well as a modern fusion influence in perfect harmony.












Sol de Mexico
Multiple Locations
soldemexicorestaurants.com
508-966-4000

Family-owned restaurant, striving to provide a unique experience to each and every one of our customers. Offering a variety of dishes from different regions of Mexico along with specially crafted cocktails and margaritas with the best tequilas around! This community is like our second family, and our goal is to continue satisfying them each and every day. We do it all, dine-in, take out, specials, catering, parties, and even live entertainment!
Acapulcos Mexican Family Restaurant & Cantina Milford
Multiple Locations
acapulcos.net
508-478-7197

Muffin House Cafe
116 Main St, Medway muffinhousecafe.com
508-533-6655

Muffin House Cafe’s coffee is roasted locally by Red Barn Coffee Roasters in Hopkinton, MA. We brew over 30 flavors daily with no syrups added. We also offer a full espresso bar as well as a variety of iced and hot teas as well as frozen coffees.


Sol de Mexico
Multiple Locations
soldemexicorestaurants.com
508-966-4000

Family-owned restaurant, striving to provide a unique experience to each and every one of our customers. Offering a variety of dishes from different regions of Mexico along with specially crafted cocktails and margaritas with the best tequilas around! This community is like our second family, and our goal is to continue satisfying them each and every day. We do it all, dine-in, take out, specials, catering, parties, and even live entertainment!
Acapulcos Mexican Family Restaurant & Cantina Milford
Multiple Locations
acapulcos.net
508-478-7197
Wright’s Dairy Farm and Bakery
200 Woonsocket Hill Rd, North Smithfield wrightsdairyfarm.com
401-767-3014


Oasis Patio @ Doubletree Boston-Milford 11 Beaver St, Milford BostonMilford.DoubleTree.com
508-478-7010

Welcome to the Oasis in the middle of Milford! Our outdoor patio restaurant and bar serves drinks and food all summer long. We feature live local music on the weekends, and special themed nights throughout the season, including movie nights and more!

Coachmen’s Lodge
273 Wrentham Rd, Bellingham coachmenslodge.com
508-883-9888


30 Main St, Hopkinton bluesquarepizza.com
508-435-0001

Blue Square Pizza is an artisan sourdough pizzeria. We offer four distinct pizza styles: Chicago cracker thin, New York style round pies, grandma style, and our signature Detroit style. Our pizza crust sets us apart. We naturally leaven our dough, carefully select local and organic flours, and employ bread baking techniques to optimize flavor. Our unique

85 E Main St, Milford olivasmarket.com
508-473-7920

Oliva’s is a family owned and operated Italian market, deli, catering business, and gift shop that has been serving the Greater Milford area for over 60 years. We provide a variety of homemade Italian foods and baked goods including porketta, sandwiches, calzones, pizza, homemade Italian sausage, and a variety of desserts. Our catering menu makes planning your

























PJ’s Bar & Grill
191 Mechanic St, Bellingham facebook.com/PjBarGrill
508-657-1787

Indulge in the best sandwiches at PJ’s Bar & Grill in Bellingham! Choose from 14 delicious sandwiches and 9 flavorful wraps, perfect for a satisfying lunch or dinner. If you can’t stay and chat, you can always grab your favorite food to-go and enjoy the taste of PJ’s wherever you are!

New England Steak & Seafood
11 Uxbridge Rd, Mendon nesteakandseafood.com
508-473-5079
NKing Street Cafe
390 King St, Franklin kingstreetcafe.com
508-541-7117


The Curry House
418 W Central St, Franklin thecurryhouse.com
508-520-2900
S

erving fine Indian food for over 9 years in Franklin, MA. The Curry House offers lunch buffet 7 days a week and cozy dining room service outfitted with white table cloths for dinner. There is also full bar service. The Curry House has a drive-through window where your orders can be called in or ordered online at www.thecurryhouse.com. We offer off-property catering available for corporate and special events.
PJ’s Smoke ‘N’ Grill
112B Main St, Medway pjsmedway.com
508-321-1193

ew England Steak and Seafood has been owned and operated by the Quirk family since 1956. For over 50 years, we have been providing the area with unsurpassed excellence in casual dining, in a quaint Old New England atmosphere.
Pirate’s Cove
74 Providence Rd, Whitinsville piratescovema.com
508-234-0700


PJ’s Bar & Grill
191 Mechanic St, Bellingham facebook.com/PjBarGrill 508-657-1787


Experience the ultimate sports bar at PJ’s in Bellingham! Sports memorabilia decorates every wall, 13 HD TVs ensure you never miss a play, and surround sound amps up the game day atmosphere. Play Keno, enjoy buzzers for touchdowns, goals, and baskets— PJ’s is where sports fans belong!
Turtle Tavern
72 Main St, Milford facebook.com/turtletavernbar
508-478-1097


Nelly’s Sandwich Shop
113 Central St, Milford facebook.com/nellyssandwichshop 508-634-8144

We are not just a sandwich shop. We have fresh homemade meals daily, homemade soups, a full
















New England Steak & Seafood
11 Uxbridge Rd, Mendon nesteakandseafood.com
508-473-5079

New England Steak and Seafood has been owned and operated by the Quirk family since 1956. For over 50 years, we have been providing the area with unsurpassed excellence in casual dining, in a quaint Old New England atmosphere.

Ichigo Ichie
837 W Central St, Franklin ichigoichieus.com
508-541-8881
IIchigo Ichie
837 W Central St, Franklin ichigoichieus.com
508-541-8881


Sol de Mexico
Multiple Locations
soldemexicorestaurants.com
508-966-4000

Family-owned restaurant, striving to provide a unique experience to each and every one of our customers. Offering a variety of dishes from different regions of Mexico along with specially crafted cocktails and margaritas with the best tequilas around! This community is like our second family, and our goal is to continue satisfying them each and every day. We do it all, dine-in, take out, specials, catering, parties, and even live entertainment!
Acapulcos Mexican Family Restaurant & Cantina Milford
Multiple Locations
acapulcos.net
508-478-7197

chigo Ichie stands for “one chance, one encounter” and is the kind of hospitality we strive to achieve. At Ichigo Ichie, one can find traditional Japanese cuisine as well as modern influence in perfect harmony. Whether it be casual dining or that special occasion, Ichigo Ichie is just the right place for you. Choose to sit at the bar or lounge for a casual night or stay in our dining room for a more private ambiance.
Tokyo Japanese Steak House
121 Depot St, Milford Find us on Facebook
508-478-7788


The Rome Restaurant
4 E Central St, Franklin the-rome.com
508-528-4740


Established in 1965 by Eugenio and Filomena Colace. As the family enters its 2nd generation, The Colace Brothers are proud to carry on the tradition of serving delicious homemade Italian cuisine at an affordable price. All of our soups, sauces, entrees and pizzas are made fresh in our kitchen daily. We take pride in making our homestyle Italian cooking to be among the best.
The Corner Market Holliston
12 Concord St, Holliston cornermarketholliston.com
774-233-1966

















The Moonlight Chef LLC
TheMoonlightChef.net
617-548-8873
Ifound my love for food and cooking at a very young age. While watching my mother and grandmother cook and entertain, I realized that the kitchen, with all its wonders, was where I belonged. I bring my passion and love for food to your table. Believing in the idea that good food can be simple, elegant, fun, exciting, comforting, and delicious. Cooking is a lifelong love. It is an extension of my personality, family traditions, and nurturing nature.
Galliford’s Restaurant & Tavern
2 Southwick St, Mendon gallifords.com
508-928-0928


Galliford’s Restaurant & Tavern
2 Southwick St, Mendon gallifords.com
508-928-0928


LJ & L Catering
112 Main St, Medway
jandlcatering.net
617-852-7127

We will cater any event. From small, intimate dinners, to large family functions, weddings, corporate outings, luncheons, we will go above and beyond to fulfill every aspect of your party. All of our food is made fresh, from scratch, by our executive chef and his talented staff. We will personalize a menu according to your needs and tastes. J & L Catering believes that your guests are the most important part of any event. Leave the details to us!
The Black Harp Mobile Irish Pub
theblackharp.com
508-954-4738

ocated at Southwick’s Zoo, Galliford’s Restaurant & Tavern brings upscale New England fare in a cozy rustic setting to Mendon, Massachusetts. Boasting beautiful views, a cozy atmosphere and farm fresh ingredients, Galliford’s delivers a great family experience. We are the perfect venue for a variety of events including weddings, showers, corporate outings and more. Our knowledgeable and friendly staff are here to help you from start to finish.
Alicante Restaurant & Lounge
84 Uxbridge Rd, Mendon alicanterestaurant.com
508-634-8188


Restaurant 45 45 Milford St, Medway 508-533-8171
We maintain a comfortable and welcoming atmosphere from our dining room and lounge to our delightful patio and outdoor eating area. Our main dining room has an elegant and intimate presence, and our fully-stocked bar and 1400 square foot cocktail lounge is great for an entertaining evening any night of the week. We also have function rooms to serve parties of up to 70 people, or we can bring our delicious food to you with our convenient catering.


Alicante Restaurant & Lounge
84 Uxbridge Rd, Mendon alicanterestaurant.com
508-634-8188


La Cantina Winery
230 Cottage St, Franklin lacantinawinery.com 978-450-1111

La Cantina Winery was born out of our love of traditional Italian winemaking with friends and family. We built our winery on the basis of community, conversation, creativity, and curiosity. Our award winning wines are produced on site using the same traditional methods my grandfather taught me. Enjoy tapas and wine at our new location. Come in as strangers, leave as friends.
New England Steak & Seafood
11 Uxbridge Rd, Mendon nesteakandseafood.com
508-473-5079
















At Oakwoods we’re dedicated to helping our customers achieve their dream landscape. We believe that there’s no better way to slow down and enjoy the little moments than by spending time outdoors with family and friends. Let us help you turn your ideas into a beautifully designed and installed space. We serve all of eastern Massachusetts with one goal in mind: create a personalized landscape for your home or business that is as unique as you are.
Our services include: Patios, pools, decks and porches, outdoor kitchens, outdoor fireplaces, fire pits, walkways, walls, front steps, outdoor lighting, landscapes and plantings, arbors and pergolas, and water features.


Notturno Home Services
1271 Pulaski Blvd, Bellingham notturnohome.com
508-922-4335

Notturno Home Services has been servicing Bellingham and its surrounding towns for over 15 years. We are a family run, family focused business. Our mission is to provide the highest level of service and workmanship for our clients and community. We pride ourselves on creating lasting relationships with our clients by exceeding their expectations and by gaining their trust through exceptional craftsmanship.
All-Temp Systems Mechanical, LLC
16 Pond St, Milford alltempsystems.com
508-966-8318


OB Marble and Granite Inc
333 S Main St, Hopedale obmarbleandgranite.com
508-488-6516

OFrank’s Appliance
331 Main St, Milford franksappliance.com
508-473-1309

AB Marble and Granite is a renowned name in the New England area with many years of experience with the installation and sale of natural and engineered stones. If you want quality marble, granite or quartz kitchen countertops, vanities, fireplaces, jacuzzis, cabinets, tile and more, then, your dreams become our concern. We take care of the measurement, planning, design, and installation.
Koopman Lumber & Hardware
Multiple Locations
koopmanlumber.com
508-234-4545

ppliance Dealership Frank’s Appliance Service has been serving New England’s appliance needs for over 40 years. Our knowledge on the appliances we sell sets us high above the competition. Frank’s Appliance Service is an authorized dealer of such brands as Amana, Avanti, Bertazzoni, Café, Viking, Verona and more. We can help you select your new appliance purchase at any budget.
Simon’s Furniture
8 Summer St, Franklin simonfurniture.com
508-528-0501


Lovejoy Carpet Cleaning
142 E Main St, Milford
lovejoycarpetcare.com
508-922-7379


Our mission is to provide our customers with a healthy indoor environment by removing many of the indoor contaminants. This includes dirt, grime, odors and irritants that trigger allergic reactions. Throughout our history we have developed superior technology and processes with one goal in mind— a healthy indoor environment.
Imperial Cleaning Services
430 Franklin Village Dr, Franklin imperialcsi.com
508-525-2315
















Milford Hardwood Floors Inc
138 S Main St, Milford milfordhardwood.com
508-473-1207

If you’re looking for quality brand-name hardwood flooring products, look no further than Milford Hardwood Floors Inc. Stop by our showroom and view our wide selection of solid, engineered, unfinished and pre-finished hardwood flooring. We also have a wide selection of luxury vinyl plank flooring. We install them too!
Carpet Lover Plus Inc
640 Douglas St, Uxbridge carpetloverplus.com
508-278-5657


Lobisser & Ferreira Construction Corp.
lobisserferreira.com
508-488-6433
We are a locally owned construction company founded upon the principles of integrity, hard work, and outstanding craftmanship. We specialize in commercial building and development, general contracting, project management, and design build projects. We pride ourselves on being a local builder deeply rooted in every community where we build. We offer an end-to-end client experience with seamless communication, budgeting, and on-site organization.
C R Schmall Building & Remodeling LLC
crschmall.com
508-528-2295











OB Marble and Granite Inc
333 S Main St, Hopedale obmarbleandgranite.com 508-488-6516

OB Marble and Granite is a renowned name in the New England area with many years of experience with the installation and sale of natural and engineered stones. If you want quality marble, granite or quartz kitchen countertops, vanities, fireplaces, jacuzzis, cabinets, tile and more, then, your dreams become our concern. We take care of the measurement, planning, design, and installation.
Modern Design & Build LLC
531 Concord St, Holliston designbuildmodern.com 508-308-1188
















OB Marble and Granite is a renowned name in the New England area with many years of experience with the installation and sale of natural and engineered stones.

If you want quality marble, granite or quartz kitchen countertops, vanities, fireplaces, jacuzzis, cabinets, tile and more, then, your dreams become our concern.
We take care of the measurement, planning, design, and installation. We offer a wide range of products and stones originally from the best world destination.

There is only one way to turn an ordinary home into a sophisticated, glamorous castle. From expert advice on the selection to the fulfillment of your vision. Our work is in three words: TRADITION, GUARANTEE & QUALITY.









Core Electrical Services LLC
149 Uxbridge Rd, Mendon coreelectricalservices.com
508-922-0599

Core Electrical Services LLC is a full service, commercial and residential electrical contracting company providing all phases of electrical installation and repair work throughout the New England area! We have an extremely dedicated and talented team of electricians with years of experience, which gives us the ability to offer such a wide array of electrical based services. We look forward to meeting you and your project needs!
Scott M Haynes Electrician Inc
18 Maddie Way, Bellingham
Find us on Facebook 508-922-6557















ETS Equipment Rental
11 Airport Rd, Hopedale etsequipmentrental.com 855-543-8387

At ETS Equipment Rental, we are set on making equipment rental easier for everyone. We provide forklifts, boom lifts, scissor lifts, excavators, mini excavators and skid steers. ETS continues to grow everyday, committed to offering you the help you need, with the best price, great service and even better quality. Learn more at our website: www.etsequipmentrental.com.
495 Rental Center
189 Medway Rd, Milford 495rental.com
508-473-5022


Wild Birds Unlimited
215 Franklin Village Dr, Franklin wbu.com/franklinma
508-541-6800

Wild Birds Unlimited, located in Franklin, MA, is part of the original and largest franchise system of backyard bird feeding and nature specialty stores with more than 350 locations throughout the United States and Canada. Wild Birds Unlimited specializes in bringing people and nature together with bird feeding and nature products, expert advice and educational events. Visit our website and shop online at www.wbu.com/franklinma.
Angel’s Garden Center
285 W Main St, Hopkinton angelsgardenandcafe.com
508-589-4583


Simon’s Furniture
8 Summer St, Franklin simonfurniture.com
508-528-0501

Simon’s is a family owned furniture, mattress and appliance store located in downtown Franklin, MA. We specialize in custom, quality, American-made furniture. Our design consultants will help you match the perfect piece for your home or we can work on a whole new design.
The White Belle Home
62 Main St, Upton Find us on Facebook 508-277-5667


Master Roof Inc
2 Main St, Milford masterroof.com 888-333-7006

Master Roof Inc is a family trusted roofing company offering our customers complimentary service when we replace a roof. There is no better time to replace or install new seamless gutters, or get your existing gutters cleaned. We try bring solutions to fit every homeowner’s budget. We offer leaf guards to avoid the gutters getting clogged and save in maintenance. Call today! We focus on the details to get the best solutions.
Rison Seamless Gutters
57 Gaulin Ave, Woonsocket facebook.com/risonseamlessgutters 401-390-0685






151 Maple St, Bellingham mcoelhogroup.com
508-966-2700

Providing premier solutions for property care, lasting improvements, and easy dumpster rentals. Our success is built on a foundation of excellence and customer satisfaction. We prioritize delivering exceptional services and have earned the trust and loyalty of our valued clients over the years. Every project we undertake receives our utmost care and attention as our passionate team strives to exceed client expectations.
Landscape Services
UrakeWeTake.com
508-498-6361










Asphalt Engineering
190 Farm St, Bellingham asphaltengineering.net
508-541-8300


The goal at Asphalt Engineering is to exceed client expectations. This starts from the first phone call through to the completion of the project. They value and respect every client and understand the importance of transparency and a personal experience. With a team that is rewarded for quality craftsmanship and a dedicated customer service department, their stellar reputation precedes them.
Oakwoods Landscape Construction Inc
1275 Main St, Millis oakwoodslandscaping.com
508-376-5197




















Medway Oil & Propane Co., Inc
37 Broad St, Medway medwayoilpropane.com
508-533-6561

Medway Oil & Propane is a fullservice oil and propane company. We have our own in-house service technicians that can help with your routine service needs and provide 24/7 emergency service. We offer great new customer specials and we offer veteran, military and first responder discounts. We also support all of the local communities we serve. Visit www.medwayoilpropane.com for more info.
Hannon Heating & Air Conditioning LLC
25 Rondeau Rd, Bellingham hannon-hvac.com
508-282-1000


Radiant Cleaning Services Inc.
703 Waverly St, Framingham radiantcleaning.com
508-361-4910

ECrystal Pool and Spa
95 Mechanic St, Bellingham crystalpoolstore.com
508-966-1322

Cxcellent customer service and expertise. Radiant Cleaning Services, Inc. is a privately owned commercial and residential cleaning service; our main priority is all about our customers. We continuously strive to provide outstanding service and value. Our customers constantly rate our service highly, and many recommend us to acquaintances.
Speedy Cleaning Company
396 Washington St, Wellesley Hill
speedycleaningcompany.com
978-760-9848


rystal Pool Store offers a complete range of high quality above ground swimming pools, inground liners, pool and spa supplies, pool parts, pumps and filters, and seasonal pool opening and pool closing service. We serve clients in the greater Bellingham, Milford, Hopkinton, Franklin, MA, area and surrounding towns in Metro West. We carry the leading brands of automatic pool vacuum cleaners to keep your pool sparkling clean all season long.
Pool Pro & Spa
161 Pulaski Blvd, Bellingham facebook.com/johnmurraypools
508-883-8777




Welcome to Medway Oil & Propane, MO&P - a full-service fuel company that you can trust with your family’s well-being and comfort. We have served the Metrowest Massachusetts area for over seven decades. As specialists in all aspects of total indoor and outdoor comfort, we have the trained personnel, experience, and equipment to fulfill your needs. We offer great new customer specials and we offer veteran, military and first responder discounts. We also support and give back to all of the local communities we serve. Visit www.medwayoilpropane.com for more info. Whether it’s fuel delivery, heating or cooling equipment installation and service, we do it all!








Gastaldo Waste & Recycle
72 Nickerson Rd, Ashland gastaldowaste.com 508-315-7651

At Gastaldo Waste & Recycle, we take pride in offering consistent, reliable residential trash and recycling collection services at an affordable rate. Our customers rave about our friendly drivers and admire our fleet of shiny new trucks. Experience top-tier service with a personal touch. Call us today and discover why Gastaldo Waste & Recycle is the trusted

Shawn’s Landscaping
Find us on Facebook 774-573-0326
As a small business, we will work personally with you to turn your backyard dreams into realities. Have an idea? We will design, develop, and implement it, until your idea comes to fruition. We see potential in every space and pride ourselves on transforming landscapes down to the last detail!










Shawn's Landscaping is a trusted small, local landscaping company that specializes in creating outdoor spaces of unparalleled beauty. With a focus on patios, retaining walls, planting, and landscape design, they transform ordinary landscapes into extraordinary showcases. Their skilled team combines creativity and expertise to bring clients' visions to life, crafting functional and aesthetically pleasing environments. Shawn's Landscaping prides itself on delivering personalized service, attention to detail, and remarkable results that enhance the natural beauty of any property.




























Simon’s Furniture
8 Summer St, Franklin simonfurniture.com
508-528-0501

Simon’s has the area’s largest selection of mattresses! Try over 40 in store from Sealy, Stearns & Foster and Tempurpedic. Simon’s has the lowest prices on all mattresses and free delivery with any mattress purchase over $999. Let us help you find a better night’s sleep with sheets, pillows and accessories to help you create the perfect sleep system.
Sundeen Furniture
241 Providence Rd, Whitinsville
508-234-8777


Modern Design & Build LLC
531 Concord St, Holliston designbuildmodern.com
508-308-1188

Modern Design & Build, based in Holliston, MA, is a family-owned and operated designbuild contracting business. We specialize in custom carpentry, interior and exterior paint, bathrooms, kitchens, basements, decks and additions. We take pride in our craftsmanship and our commitment to our customers.

Outdoor Personia
1048 S Main St, Bellingham outdoorpersonia.com
508-883-4043
THusky Painting Contractors
1 Watson Ave, Worcester huskypaintingcontractors.com
508-414-1055

he Outdoor Personia team provides complete project management including designing, permitting, site preparation, and construction of outdoor living structures and accents. Our sales process is all about relationships as we want people to feel welcomed when visiting our design centers. We do not push clients to price lists, catalogs, or ordering online, as we prefer to first understand their needs and then make recommendations accordingly.
Coletta’s Furniture
598 Wood Ave, Woonsocket colettasfurniture.com 401-597-5911


Asphalt Engineering
190 Farm St, Bellingham asphaltengineering.net
508-541-8300


Call today for a complimentary estimate and get what you’re paving for! Asphalt Engineering: “Same trusted name since 2005.” This local, family owned, paving and asphalt maintenance company only uses the latest equipment, MA Certified asphalt plants, and highly experienced professionals. They are the obvious choice for your asphalt needs. Standing behind their generous warranties is of utmost importance and reflects in their online reputation.
Harshaw Paving Reclamation
1025 Quaker Hwy, Uxbridge harshawpaving.com
508-409-6439




Multiple Locations
dtpest.com
508-966-4470

We are a family owned business, servicing homes and commercial properties for over 25 years. We help them control termites, mice, ants, mosquitoes, bats, and wasps. We provide our customers with the best possible treatment, from wildlife and rodent control to eliminating insects from spaces occupied by people. Our team is always working to meet and even exceed your pest control expectations, making us the last pest control company you need.
Find us on Facebook
508-768-8274






If you are a local Bellingham business please consider joining! Be a part of the positive movement in our community. Scan QR code to visit our website.







Notturno Home Services
1271 Pulaski Blvd, Bellingham notturnohome.com
508-922-4335

Notturno Home Services has been servicing Bellingham and its surrounding towns for over 15 years. We are a family run, family focused business. Our mission is to provide the highest level of service and workmanship for our clients and community. We pride ourselves on creating lasting relationships with our clients by exceeding their expectations and by gaining their trust through exceptional craftsmanship.
Paul Flaherty Plumbing & Heating
186 Fountain St, Framingham flahertyplumbing.com
508-653-1775


Crystal Pool and Spa
95 Mechanic St, Bellingham crystalpoolstore.com
508-966-1322

Crystal Pool Store offers a complete range of high quality above ground swimming pools, inground liners, pool and spa supplies, pool parts, pumps and filters, and seasonal pool opening and pool closing service. We serve clients in the greater Bellingham, Milford, Hopkinton, Franklin, MA, area and surrounding towns in Metro West. We carry the leading brands of automatic pool vacuum cleaners to keep your pool sparkling clean all season long.
B & L Pools & Spas
303 N Main St, Uxbridge blpools.com
508-278-3766




Modern Design & Build LLC
531 Concord St, Holliston designbuildmodern.com
508-308-1188

Modern Design & Build, based in Holliston, MA, is a family-owned and operated designbuild contracting business. We specialize in custom carpentry, interior and exterior paint, bathrooms, kitchens, basements, decks and additions. We take pride in our craftsmanship and our commitment to our customers.
C R Schmall Building &Remodeling LLC crschmall.com
508-528-2295



Master Roof Inc
2 Main St, Milford masterroof.com 888-333-7006
M

aster Roof, Inc is GAF Master Elite Certified Contractor. Our roofing system provides 50-year warranty and 25-year workmanship backed by GAF. GAF is one of the largest high-quality shingles manufacturer. This combined with our experience, training, and dedication are our tools to provide the best roofing services available. We don’t sell, we educate homeowners by getting the details and giving the best solutions. Call us and see for yourself.
Yupa’s Construction yupasconstruction.com 401-302-6051





















Marchand Environmental
Multiple Locations
marchandenvironmental.com
508-962-4887

Marchand Environmental provides septic services, land clearing, demolition, dumpster rentals, and porta potty services in Massachusetts and Rhode Island. Marchand Environmental’s Septic Service offers title 5 inspections, installs, maintenance, pumping, repairs and service.

Master Roof Inc
2 Main St, Milford masterroof.com
508-422-5020
WADC Septic
295 Lincoln St, Blackstone adcseptic.com
508-883-9000


Mass Renewables
90 Mendon St, Bellingham massrenewables.net
508-657-1116

Our goal is to provide our community with a sustainable source of energy that will allow them to be more independent, save money and lower their carbon footprint, ultimately making our world a better place to live. We believe in thinking globally and acting locally.
Momentum Solar - MA Office
50 D’Angelo Dr, Marlborough momentumsolar.com
802-399-6703

e are specialists on James Hardie Siding. James Hardie invented fiber cement siding and there are plenty of reasons why Hardie is better than wood. Fiber cement doesn’t attract pests, and resists water absorption to help resist damage from mold, swelling and cracking. With their paint finish, you won’t have to repaint every 10 years. All James Hardie siding comes with a 30 year, non prorated limited warranty.
Yupa’s Construction
yupasconstruction.com
401-302-6051








Modern Design & Build, based in Holliston, MA, is a family-owned and operated design-build contracting business. We specialize in custom carpentry, interior & exterior paint, bathrooms, kitchens, basements, decks and additions. We take pride in our craftsmanship and our commitment to our customers.







American Climbers americanclimbers.com
508-497-8628



American Climbers tree service has served the MetroWest region of Massachusetts since 1996. We specialize in large tree removal and pruning, as well as lot-clearing services. Trees are a valuable asset to your property and our environment. Trust our experts and awardwinning team to maximize your tree’s potential and value.
Welcome to Mass Renewables, where expertise meets a commitment to a cleaner future. With over 30 years in the building industry and 14 years in solar energy, our founders blend their skills to bring you top-notch residential and commercial solar solutions.


Charron Tree Service
1060 Pulaski Blvd, Bellingham Charrontreeservice.com 508-883-8823

At Mass Renewables, we are not just about solar panels; we are about independent energy sustainability. Our team is NABCEP-certified, OSHA-certified, and includes master electricians and licensed builders. This means your solar project is in the hands of experienced professionals dedicated to safety and excellence.
















Tree Removals
Tree Pruning & Trimming
Emergency Ser vices
Storm Damage
Lot Clearing
Stump Grinding
Reliable Ser vice Since 1996
FREE Estimates
All Calls Returned Discounts for Senior Citizens & Veterans
All Major Credit Cards Accepted


Royal Thermal View, Inc.
royalthermalview.com
508-473-3269
Royal Thermal View, based out of Mendon, MA, was established in 1986.

For more than 38 years, Royal Thermal View has installed new and replacement windows and doors to customers in Massachusetts and Rhode Island. Every Royal Thermal View customer receives personalized attention and is never subject to high-pressure sales!

470 Franklin Village Dr, Franklin sallysalley.com
508-520-3123
LYupa’s Construction yupasconstruction.com
401-302-6051

ocated in Franklin, MA, and serving the surrounding area for over 35+ years. Sally’s Alley offers the complete line of Hunter Douglas blinds, shades, sheer shadings and shutters, as well as custom draperies and top treatments. Shop with Sally’s Alley and you’ll get the best national brands, superlative service and reliable expertise— all provided with a local touch because we are independently owned and operated. Visit us today!


8 Sutton St, Northbridge curtainfactoryoutlet.com
508-234-2944















Lobisser Ferreira Construction Corp. is a locally owned construction company founded upon the principles of integrity, hard work, and outstanding craftmanship. Partners Kevin Lobisser and Joe Ferreira have over 50 years combined experience building both commercial projects and residential homes. In 2010, Kevin and Joe combined their talents and built their company on strong ethics, with years of experience and valuable knowledgeable employees. Lobisser Ferreira has become one of the most highly regarded construction companies in the area. Despite their tremendous growth, Kevin and Joe have not lost sight of what is most important, satisfied customers.











BUILDING TRUST WITH QUALITY WORK.



















94 & 96

A great family law attorney helps solve problems, not create them. After a fourteen-year career working directly with Judges in the Probate and Family Court, Attorney Burns built a repertoire of professional relationships, persuasive arguments and strategies to efficiently navigate the court system. Realistic expectations and practical solutions are the hallmark of the legal representation clients receive from Attorney Burns. Whether utilized in the context of litigation or mediation, Attorney Burns helps clients find fair and just resolutions to their legal problems. Stop by our offices at 35 Main Street Hopkinton, MA 01748 or give us a call at (508) 589-4848.




Consigli and Brucato PC
189 Main St, Milford consigliandbrucato.com
508-478-2054

Consigli and Brucato PC is primarily devoted to real estate conveyancing; however, we have a substantial practice in divorce, family law, child custody, personal injury law, workers compensation law, criminal law, small business organization, bankruptcy, probate, and drafting of wills. Each of the attorneys in our firm is experienced in both trial and appellate practice in all courts in the Commonwealth as well as the local federal courts.
The Law Offices of James G. DeGiacomo
196 Main St, Milford bostonmassduiattorney.com 617-941-3666


Mirick O’Connell
100 Front St, Worcester mirickoconnell.com
508-791-8500

EBurns Law Office, P.C.
35 Main St, Hopkinton burnsesq.com
508-589-4848

Gxcellence in our work. Excellence in client service. Excellence in value. Mirick O’Connell is a full-service law firm with offices in Worcester, Westborough and Boston. The firm’s practice areas include Business; Creditors’ Rights, Bankruptcy and Reorganization; Construction Law; Family Law/ Divorce; Health Law; Labor, Employment and Employee Benefits; Litigation; Personal Injury; Real Estate and Environmental Law; and Trusts and Estates.
The Wozniak Law Group, P.C.
159 E Hartford Ave, Mendon woz4law.com
508-478-3788

reat family law attorneys help solve problems, not create them. After a 14-year career working directly with judges in the Probate and Family Court, Attorney Burns built a repertoire of professional relationships, persuasive legal arguments and strategies to efficiently navigate the court system. After a 24-year career with the Department of Children & Families, Attorney Holahan specializes in DCF Fair Hearings and family law matters.
Consigli and Brucato PC
189 Main St, Milford consigliandbrucato.com
508-478-2054


Mirick O’Connell
100 Front St, Worcester mirickoconnell.com
508-791-8500


Excellence in our work. Excellence in client service. Excellence in value. Mirick O’Connell is a full-service law firm with offices in Worcester, Westborough and Boston. The firm’s practice areas include Business; Creditors’ Rights, Bankruptcy and Reorganization; Construction Law; Family Law/ Divorce; Health Law; Labor, Employment and Employee Benefits; Litigation; Personal Injury; Real Estate and Environmental Law; and Trusts and Estates.
Nealon, Nealon & Click
85 Main St Suite, Hopkinton nealonclicklaw.com
508-435-5000

Ladies and Gentlemen! Boys and Girls! And Winners of ALL categories!

Thank you for making the MyFM Quest for the Best 2024 the LARGEST AND MOST SUCCESSFUL "Best Of" contest in the state of Massachusetts.
• Over 1,600 Businesses Nominated
• 252 Different Categories
• Over 650,000 votes in just two weeks

For a complete listing of all MyFM Quest for the Best winners online, visit

Burns Law Office, P.C.
35 Main St, Hopkinton burnsesq.com
508-589-4848

At Burns Law Office, you will be greeted by our friendly legal assistant rather than an answering service. We strive to return all calls and emails within one business day, if not the same day. We believe in educating our clients on the legal issues and forwarding all correspondence with the opposing side so our clients are never left in the dark as to the issues or progress in their case. Call us today for a free consultation.
Consigli and Brucato PC
189 Main St, Milford consigliandbrucato.com
508-478-2054

Burns Law Office, P.C.
35 Main St, Hopkinton burnsesq.com
508-589-4848


BErnest H. Horn, Horn & O’Loughlin Law
12 Asylum Rd, Mendon hornlaw.org
833-244-3372

Let over 80 years of law enforcement expertise work for you. Horn & O’Loughlin are uniquely positioned to service all your legal needs. Who better to understand how the legal system works than people who have dedicated their careers to serving and protecting the public? Attorneys Horn and O’Loughlin provide a full spectrum of legal services, including litigation, mediation, risk reduction seminars and alternative dispute resolution.
Mirick O’Connell
100 Front St, Worcester mirickoconnell.com
508-791-8500

urns Law Office is the premiere family law firm in MetroWest. We offer mediation and litigation services for court matters in Middlesex, Worcester and Norfolk counties. Our office is conveniently located only 2 miles off I-495 in the Historic District of downtown Hopkinton, Massachusetts. Feel free to visit our website to submit an inquiry or call to see how we may assist you. We’ll be happy to schedule a free consultation.
Consigli and Brucato PC
189 Main St, Milford consigliandbrucato.com
508-478-2054


Law Offices of Michael M. Kaplan, P.C.
291 Main St, Miford facebook.com/KaplansLaw
508-473-1161


Aggressive, dedicated & compassionate attorney with 32 years of experience who fights for his clients. Awarded Top 100 Attorneys in the USA. Recipient of the Small Business of the Year from the Chamber of Commerce. National Register of Whose Who for Famous Attorneys. Areas of practice: Personal Injury, Family Law, Litigation, Wills & Trusts. Past President Milford Rotary Club & Milford Area Attorney Association, Chairman Summer Meals Program.
Consigli and Brucato PC
189 Main St, Milford consigliandbrucato.com
508-478-2054






Wolf Law Office LLC
54 Hopedale St, Hopedale wolfrelaw.com
508-473-9800

Wolf Law Office offers legal services in real estate such as contract preparation and review for buyers and sellers, closing services for lenders and cash buyers as well as title matters. The firm also provides probate, trust and estate planning services.



Mirick O’Connell
100 Front St, Worcester mirickoconnell.com
508-791-8500

At Gastaldo Waste & Recycle, we take pride in offering consistent, reliable residential trash and recycling collection services at an affordable rate. Our customers rave about our friendly drivers and admire our fleet of shiny new trucks. Experience top-tier service with a personal touch. Call us today and discover why Gastaldo Waste & Recycle is the trusted choice for all your waste management needs.
gastaldowaste.com | 508-315-7651





























SPORT CLIPS HAIRCUTS PGS 102 & 104

There’s something about the MVP Experience at Sport Clips that you just can’t put into words. Awesome haircut by a guy-smart stylist, hot steamed towel, invigorating shampoo, neck and shoulder treatment. It takes a haircut and turns it into an event. It takes your day and turns it into a mancation. It will have you walking out feeling ten feet tall, with the confidence that says, “Bring it on.” At Sport Clips, it’s good to be a guy.
www.sportclips.com/ma117 | www.sportclips.com/ma109



RxFitness and Health (CrossFit Never Doubt)
47 Sumner St, Milford crossfitneverdoubt.com
508-473-4560

Home of CrossFit Never Doubt, our goal is to prescribe health and fitness over the course of one’s life. We offer a robust program to cover all your health and fitness needs from group classes to one on one training to nutrition coaching to functional medicine to mobility sessions to wellness infusions. Our expert staff will be there every step of the way to guide, motivate and direct you in reaching your goals!
Country Fitness
country-fitness.com
508-603-9779


Salone de Bella
416 Washington St, Holliston salonedebella.com
508-429-2287

Sport Clips Haircuts
Multiple Locations sportclips.com/ma109

St Salone de Bella, we offer a friendly and professional atmosphere while providing the best possible hair care so you can look and feel great. We are committed to keeping your hair in the best possible condition, while creating the look that will best suit your hair and your lifestyle. We are color specialists, with stylists who have been in the business from 8 to 40+ years.
Traveler Beauty Company
1 Nipmuc Dr, Mendon travelerbeautycompany.com
508-381-0068


port Clips revolutionizes men’s and boys’ grooming with a unique sports-themed experience. Emphasizing the importance of modern grooming trends, Sport Clips offers high-quality haircare in a relaxed atmosphere. Clients love the MVP Experience. Combining style, comfort, and community support, Sport Clips sets the standard for contemporary men’s grooming.
Casey’s Cuts
3 Charlesview Rd, Hopedale
Find us on Facebook 508-381-3142


The Lash Lounge Milford Crossing
Multiple Locations
thelashlounge.com/ma-milford-crossing 508-469-5274

Welcome to The Lash Lounge Milford, where we’ve delivered premier eyelash experiences since 2019. Our skilled lash stylists ensure a luxurious experience tailored to your unique beauty needs. With personalized consultations and expert techniques, we enhance your natural beauty with stunning lash and brow services. Ready to own your confidence? Book an appointment at The Lash Lounge Milford now!
Traveler Beauty Company
1 Nipmuc Dr, Mendon travelerbeautycompany.com 508-381-0068



Traveler Beauty Company
1 Nipmuc Dr, Mendon travelerbeautycompany.com
508-381-0068

Traveler Beauty Company is a beautiful full-service salon with a warm and welcoming environment, conveniently located on RT 16. TBC is an award-winning bridal hair and makeup company and we are excited to provide the same outstanding service and experience to clients looking for hair, nail, tanning and esthetic services. Our dedicated team provides nothing less than exceptional work by tailoring every service to accommodate the individual guest.
Spellbound Skin Studio
57 E Main St, Westborough spellboundskinstudio.com
508-779-6495


Salone de Bella
416 Washington St, Holliston salonedebella.com
508-429-2287

ARxFitness and Health (CrossFit Never Doubt)
47 Sumner St, Milford crossfitneverdoubt.com
508-473-4560

Ht Salone de Bella, we offer a friendly and professional atmosphere while providing the best possible hair care so you can look and feel great. We are committed to keeping your hair in the best possible condition, while creating the look that will best suit your hair and your lifestyle. We are color specialists, with stylists who have been in the business from 8 to 40+ years.
Dellaria Salon
785 Washington St, Holliston dellaria.com
781-778-0674


ome of CrossFit Never Doubt, our goal is to prescribe health and fitness over the course of one’s life. We offer a robust program to cover all your health and fitness needs from group classes to one on one training to nutrition coaching to functional medicine to mobility sessions to wellness infusions. Our expert staff will be there every step of the way to guide, motivate and direct you in reaching your goals!
Whitin Community Center
60 Main St, Whitinsville WhitinCommunityCenter.com
508-234-8184


Sport Clips Haircuts Multiple Locations sportclips.com/ma109

There’s something about the MVP Experience at Sport Clips that you just can’t put into words. Awesome haircut by a guy-smart stylist, hot steamed towel, invigorating shampoo, neck and shoulder treatment. It takes a haircut and turns it into an event. It takes your day and turns it into a mancation. It will have you walking out feeling ten feet tall, with the confidence that says, “Bring it on.” At Sport Clips, it’s good to be a guy.
live.love.BARRE.
38 E Central St, Franklin livelovebarre.com 508-440-5553









A local family owned farm, farmstand, apple orchard, greenhouses and hydroponic farm. You-pick apples and hayrides, fresh vegetables, strawberries, peaches and other tree fruit, free range eggs and greenhouses full of beautiful flowers.
We grow a majority of our crops hydroponically and we provide you with an oppor tunity to own your own ver tical growing system!







1 Nipmuc Dr, Mendon travelerbeautycompany.com
508-381-0068

Traveler Beauty Company is a beautiful full-service salon with a warm and welcoming environment, conveniently located on RT 16. TBC is an award-winning bridal hair and makeup company and we are excited to provide the same outstanding service and experience to clients looking for hair, nail, tanning and esthetic services. Our dedicated team provides nothing less than exceptional work by tailoring every service to accommodate the individual guest.
The Parlour At Chat Noir
324 Village St, Medway vagaro.com/theparlouratchatnoir
508-887-6185

Family Karate Center
96 Church St, Whitinsville familykaratecenter.net
508-234-0900


SEvery Bodies Massage
35 Main St, Hopkinton every-bodies.com
508-603-9779

Every Bodies offers a wide range of massage services, including Swedish, Deep Tissue, Sports, Prenatal, Myofascial Release and Chair Massage. Enhance your massage with hot stones, mud wraps, scrubs, essential oils, and paraffin dips. Immerse yourself in the benefits of massage in our tranquil treatment room. Whether you are looking for a soothing relaxation massage or seeking relief from chronic pain, your massage is tailored to meet your needs.
Spellbound Skin Studio
57 E Main St, Westborough spellboundskinstudio.com
508-779-6495

pecializing in self-defense, character development, and life skills, we have had the honor of serving the Blackstone Valley since 1982. Our highly experienced instructors that understand the psychology behind teaching will help you or your child to gain better focus, self-esteem and self discipline in a safe and fun environment. Carefully designed classes for ages 3.5 through adult.
NCK Bellingham
799 S Main St, Bellingham nckbellingham.com
508-594-9246


The Glow Factory By Jessie Dillon Beauty 165 Main St, Medway theglowfactoryma.net
774-287-5358


The Glow Factory is the area’s leading destination for permanent makeup. At TGF, we are committed to high-level artistry, the strictest safety standards, and continued education. These 3 pillars are what set us apart, and what helped us earn 300+ 5-Star reviews across Google and Facebook. We are now offering a 100% Satisfaction Guarantee, a “pay later” option, and in-studio and FaceTime consultations. It’s time to “Wake Up With Your Makeup!”
Rectify Barbershop & The Beauty Alcove
752 Main St, Walpole rectifybba.com 774-284-4043


Scarlet Spa
12 Grafton Common, Grafton scarletspa.org
774-293-1002

Scarlet Spa is a cozy, boutique spa offering skin care services, microchanneling, waxing, lashes, massage, integrative stretch and a salt therapy room. Services are customized and thoughtful with an attention to detail, offered in a relaxing and inviting atmosphere on historic Grafton Common. The Spa offers three skin care lines, locally made items and gifts, CBD muscle recovery creams, crystals and jewelry for your self care and gift giving.
Purely You Aesthetic Boutique
755 Washington St, Holliston purelyboutique.com
774-233-6005



The Glow Factory is the area's leading destination for permanent makeup. At TGF, we are committed to high-level artistry, the strictest safety standards, and continued education. These 3 pillars are what set us apart, and what helped us earn 300+ 5-Star reviews across Google and Facebook. We are now o ering a 100% Satisfaction Guarantee, a "pay later" option, and in-studio & FaceTime consultations. It's time to "Wake Up With Your Makeup!"

Traveler Beauty Company
1 Nipmuc Dr, Mendon travelerbeautycompany.com
508-381-0068

Traveler Beauty Company is a beautiful full-service salon with a warm and welcoming environment, conveniently located on RT 16. TBC is an award-winning bridal hair and makeup company and we are excited to provide the same outstanding service and experience to clients looking for hair, nail, tanning and esthetic services. Our dedicated team provides nothing less than exceptional work by tailoring every service to accommodate the individual guest.
Salone de Bella
416 Washington St, Holliston salonedebella.com
508-429-2287







•
•
•
Find more than your next job.
At Milford Regional Medical Center, a big part of our culture is driven by our relationship with our local community. They support us, and we support them. It is this partnership with our community that has allowed us to become a successful, thriving medical center. Are you ready to work where your contributions are appreciated?
If you want
learn more about this exceptional place, please consider applying













EXPERIENCE THE UNPARALLELED LIFESTYLE OF SALMON AT MEDWAY. Situated on 57 acres of breathtaking scenery along the Charles River in MetroWest Massachusetts, our resort-style campus offers more than just a home – it’s a vibrant community designed for active adults. With no shortage of opportunities to thrive and indulge in the best life has to offer, discover why SALMON at Medway is the premier destination for luxury living.






Shannon Delaney has been providing compassionate, individually tailored geriatric care for over 20 years. Specializing in complex case management, coordination of care and services, and assessment and placement in care communities. Shannon is committed to helping aging adults and their families navigate the sometimes confusing— and oftentimes overwhelming— realm of high-quality elder services, whether through identifying and managing services that allow a loved one to age safely in place, or through assessing their functional and social-emotional care needs and identifying “right fit” care communities. Shannon is licensed and insured in Massachusetts and Rhode Island, and holds a Master’s degree in Social Work from Boston College.

Cedar Chiropractic & Sports
77 W Main St, Hopkinton cedarchirosports.com
508-435-8182

Our chiropractic services offer the best alternative therapy to help you live a pain free life. With our experienced chiropractor, we provide personalized care that targets the root cause of your pain, bringing you long lasting relief. We offer a non-invasive and holistic approach ranging from dry needling, IASTM, laser, myofascial active release, regenerative medicine, radiofrequency, shockwave, spinal decompression, and spinal manipulation.
Sanford Nutrition Consulting
847 Washington St, Holliston sanfordnutrition.com 857-302-2964


Cedar Chiropractic & Sports
77 W Main St, Hopkinton
cedarchirosports.com
508-435-8182

Cornerstone at Milford Assisted Living & Compass Memory Support
11 Birch St, Milford seniorlivingresidences.com
508-473-0035

Cur provider bends manual chiropractic manipulation therapy with deep muscular therapy and physical rehabilitation program resulting toward a more patientcentered results-based care. Our team has sought out the majority of the certification programs available in this field and has spent the last two decades compiling a completely unique and diverse set of knowledge and experience resolving pain and injury with the tools and skills acquired.
Palmer Family Chiropractic
114 Water St, Milford
milfordchiropractor.com
508-478-2008


ornerstone at Milford offers seniors service-enriched assisted living and a state-of-the-art Compass Memory Support Neighborhood® designed to treat the symptoms of dementia and Alzheimer’s in a comfortable and dignified residential setting. Residents benefit from maintenance-free living, high quality personal care, a full daily program calendar, and an award-winning dining program.
Adviniacare Northbridge
85 Beaumont Dr, Northbridge adviniacare.com
508-234-9771


192 West St, Milford goodmanko.com
508-478-3800

We bring out the natural, beautiful best in your smile with everything from professional teeth whitening to stain-resistant porcelain veneers and full-mouth smile makeovers! Invisalign®— Our team takes a special interest in orthodontic treatment. Notably, Invisalign® presents a discreet and removable way to straighten teeth without silver-colored, fixed metal braces. We also offer precision, comprehensive dental implants.
Mint Dental of Franklin
150 Emmons St, Franklin lovemintdental.com
508-613-9513

























Dr. Goodman, Ko, Bressler & Kashefi -Advanced Cosmetic & Prosthetic Dentistry
192 West St, Milford goodmanko.com
508-478-3800

Sleep-disordered breathing— We can prevent the serious complications associated with conditions such as obstructive sleep apnea with special oral appliances, such as mandibular advancement devices or the Vivos® method. Extensive expertise to support pediatric airway health— we emphasize early intervention in childhood with oral appliances, special exercises, and a multi-disciplinary approach.
Hopkinton Dental Associates PC
77 W Main St, Hopkinton hopkintondmd.com
508-435-5455


Milford Regional Medical Center
14 Prospect St, Milford
milfordregional.org
508-473-1190

Milford Regional Medical Center, Inc. is a non-profit healthcare system that includes the Medical Center, Milford Regional Physician Group and Milford Regional Healthcare Foundation. Located at the intersection of Rts. 40 and 16 in Milford, MA, Milford Regional serves residents of 20plus towns as a 149-bed, full-service, acute-care, community and regional teaching hospital with over 300 primary care and specialty physicians on our medical staff.
Dana-Farber Brigham Cancer Center at Milford
20 Prospect St, Milford
dana-farber.org
508-488-3700


Hopkinton Audiology LLC
1 Lumber St, Hopkinton hopkintonaudiology.com
508-936-3277

Compassionate and quality care to help you hear better. Our audiologist will work collaboratively with each patient to understand and address their individual listening needs and arrive at the best possible solution for that individual. No two ears are the same. Our goal is to help our patients get back into the conversation.
Miracle-Ear
196 E Main St, Milford miracle-ear.com
508-422-9249


Hopkinton Skin Care
35 Main St, Hopkinton hopkintonskincare.com
508-272-0168

HSC offers clinical skin care treatments and medical grade home care products. I like to educate my clients and provide services that deliver the results they are looking for, whether their concerns are antiaging, acne, pigmentation or rosacea. I have services that will improve their skin health. Schedule a complimentary consultation with Kathy today!
Purely You Aesthetic Boutique
755 Washington St, Holliston purelyboutique.com
774-233-6005



AdviniaCare Northbridge
85 Beaumont Dr, Northbridge adviniacare.com
508-234-9771

For the very best in assisted living, memory care, skilled nursing and respite stay, AdviniaCare Northbridge is here for you and your family. As you drive up the hill you will see our beautiful property, where we are proud to provide a unique living experience in a historical mansion. Our exceptional team is dedicated to providing a safe and vibrant community that feels just like home to all who walk through our doors.
Dr. Goodman, Ko, Bressler & Kashefi -Advanced Cosmetic & Prosthetic Dentistry
192 West St, Milford goodmanko.com
508-478-3800


Brian Crockett Counseling, LLC
89 Main St, Milford brianccounseling.com
978-536-1056

PBlackstone Valley Family Physicians
100 Commerce Dr, Northbridge milfordregionalphysicians.org
508-234-6311

Beople come to see me when they are having a hard time with using substances. For many, drugs and alcohol are their solution and not their problem. I try to help you discover what the substances solve for you that you are having a hard time doing for yourself: relaxing, coping with stress, medicating mental health or trauma. I have a strong bias: I believe the best relapse prevention is living a life worth living.
Paula McSweeney, LICSW
35 Main St, Hopkinton psychologytoday.com
508-500-9173

lackstone Valley Family Physicians is truly committed to providing high quality health care to the residents of Blackstone Valley in a warm and compassionate environment. Our physicians are board certified in Family Practice and are trained to care for all members of your family, from birth through the elder years.
Milford Regional Physician Group
Multiple Locations milfordregionalphysicians.org 508-473-1480


Joseph & Thomas Opticians
138 S Main St, Milford josephandthomasopticians.com
508-478-3838


Our goal at Joseph & Thomas Opticians is to give to you best eyewear possible. We want you to experience what makes us the best in the area! Good value means quality care, excellent service, and fair pricing. We have been involved in the community for over 40 years and we plan to be the source for expert, convenient, and full service eyewear for years to come.
Dr. Michael J Pfeffer & Associates
480 W Central St, Franklin jeffmorrillandassociates.com
508-528-2040









Dr. Goodman, Ko, Bressler & Kashefi
-Advanced Cosmetic & Prosthetic Dentistry
192 West St, Milford goodmanko.com
508-478-3800

We can start, complete, and do everything in between to replace your missing or failing teeth with implants. This is including surgical extraction, bone graft augmentation, implant placement, gingival grafting, and all the simple or complex prosthetics that follow. We use technologies like a piezo surgery, CBCT scans, and 3-D printed surgical guide to ensure comfort and precision.
Oral Surgery Partners
208 Main St, Milford oralsurgerypartners.org
508-244-4444


Platinum Physical Therapy
Multiple Locations
platinumptma.com
508-544-1540

PDental Place Hopkinton
79 Hayden Rowe St, Hopkinton brushfloss.com 508-435-5437

Olatinum Physical Therapy is a privately owned outpatient physical therapy clinic with 4 locations in the Metrowest area. We do not use aides or assistants and all care is provided by our licensed physical therapists. All appointments are one on one for 40 minutes to provide the highest quality of care for our patients. All major insurances are accepted.
Concierge Physical Therapy
22 South St, Hopkinton conciergephysicaltherapy.com
978-517-4500

wned by Dr. Nadia Diab-Shamari, Dr. Reem Antun-Lago, and Dr. Kenneth Webb, all Metro-West residents and parents themselves, we seek to provide the highest standard of care in a caring, nurturing, and respectful environment. We’ve placed our dentists and orthodontists together in most locations to make it convenient for you to manage your whole family’s dental needs. We have 6 locations across the Metro-West area.
Family Orthodontics
184 Main St, Milford familyorthoonline.com 508-504-9507

















Pond Home
289 East St, Wrentham pondhome.org
508-384-3531

Offering residential care and supportive nursing care for over 125 years. Pond Home was created as a not-for-profit home for older adults who need support to live their lives to the fullest. We offer private rooms and suites, private bathrooms, full meal service in our dining rooms, extensive activity programing, as well as 24-hour nursing care and support. Call for a tour to find out why Pond Home is the hidden jewel of long-term care.
AdviniaCare Northbridge
85 Beaumont Dr, Northbridge adviniacare.com
508-234-9771


Milford Regional Medical Center
14 Prospect St, Milford milfordregional.org
508-473-1190

PHolliston Spine & Sports, (Dr. Michael Krupa)
25 Charles St, Holliston hollistonspine.com
508-429-7293

Fatients benefit from Milford Regional’s patient care center, which includes eight state-of-the-art operating suites and consolidated surgical services (including admitting and pre-admission testing). With a growing number of highly regarded specialists joining Milford Regional’s medical staff, the Surgery Center has become a shining center of excellence for the communities the Medical Center serves.
MetroWest Medical Center
115 Lincoln St, Framingham
mwmc.com
508-383-1000


rom young athletes to weekend warriors, Dr. Krupa and our wellness team help patients recover quickly from any sports injury. Our care will get you off the sidelines and back in the game. We believe in a complementary approach to treating back pain, neck pain and soft tissue injuries, combining chiropractic adjustments with physiotherapy.
Sports & Wellness Physical Therapy
800 Chestnut St, Franklin sportswellnesspt.com
508-528-5723


Metrowest Veterinary Associates
207 E Main St, Milford mvavet.com
508-478-7300
At Metrowest Veterinary Associates

we are pleased to provide our best care for your best friend. Our doctors and staff use the latest knowledge and equipment to provide medical, surgical, dental and preventative health care for dogs, cats, and small companion animals. It is our goal to provide a comfortable environment where both you and your pet are treated with the utmost respect and compassion.
Millis Animal Hospital
1175 Main St, Millis millisanimalhospital.com
508-376-5317






















We are so honored to have won this Gold Award and are truly appreciative to all who voted for us and have supported us throughout our careers in real estate. With the Coldwell Banker name behind us, and the exceptional training, support and superior marketing techniques we have received, we have been able to grow our real estate business into one of professionalism, honesty, hard work and dedication to all our clients. We are ready to help you!
Suzanne Ranieri suzanne.ranieri@nemoves.com | 508-380-1643
Melissa Bertonazzi melissa.bertonazzi@cbrealty.com | 508-320-3596




Multiple Locations
customhomerealty.com
508-473-4777

Custom Home Realty was created with the idea of offering a higher level of service, personal attention, and professionalism to our clients. CHR is committed to ensuring our clients are not just a number, but a member of our ever-growing family. We are proud to have created a reputation that is elevating the standards of real estate by providing exceptional service and advanced marketing techniques.
Century 21 The Real Estate Group
199 Main St, Milford century21therealestategroup.com 800-942-3922


Homefield Credit Union
Multiple Locations
homefieldcu.com
508-839-5493

CBJ Environmental
cbjenvironmental.com
508-458-5974

Eomefield Credit Union is proud to be a part of the community. We offer competitive mortgage loan products and profitable savings opportunities centered around our members’ financial success. If you live, work, or attend school in Worcester or Middlesex counties, you too can experience Banking with a Homefield Advantage! Let’s get started today!
Charles River Bank
Multiple Locations
charlesriverbank.com
508-533-8661

nvironmental testing and remediation solutions for residential, commercial, and institutional properties. Asbestos | Lead-Based Paint | Indoor Air Quality | Mold | Site Testing | Hazmat Surveys | Construction Inspections | Pre-Demolition Inspections | Project Monitoring | Work Plan Development | Compliance Testing & Inspections
Multiple Locations homequestconsult.com
508-292-2635


Lioce Properties Group
230 Main St, Milford lioceteam.com
508-422-9750


Lioce Properties sets out to build a business that exceeds their clients’ expectations, simply because that’s the only way we know how. We accomplished this goal by assembling a team of highly skilled and knowledgeable professionals who share our vision and are dedicated to providing a level of service second to none. Our belief is that a great real estate experience hinges on the relationships that we build.
Carruth Capital LLC
116 Flanders Rd, Westborough carruthcapital.com
508-898-3800





Hazardous Materials Testing (Comprehensive HBMS).





Suzanne Ranieri & Melissa RanieriBertonazzi Coldwell Banker Realty Team
Multiple Locations
sueranierisellsrealestate.net
508-380-1643

Providing all of our clients with exceptional customer service is something we have always strived for. Our goal is to make buying or selling your home as worry-free as possible by always listening to your needs and concerns and keeping the lines of communication open at all times. We will continue to work with you every step of the way to your successful closing. Customer service is our #1 priority.
Custom Home Realty
Multiple Locations customhomerealty.com
508-473-4777


ReMax Executive Realty- Chuck Joseph
22 South St, Hopkinton
508-435-5353
F ormer teacher and high school basketball coach, Chuck Joseph formally began the business of helping clients buy and sell homes in 1985. Over the past 35 years, he has helped hundreds of clients through the sometimes difficult maze of home ownership. He has tremendous experience in both new construction and re-sales. During that time, he has built relationships with builders, trades people, town officials, and hundreds of other real estate agents.


Multiple Locations customhomerealty.com
508-473-4777
CSuzanne Ranieri & Melissa Ranieri-Bertonazzi Coldwell Banker Realty Team
Multiple Locations
sueranierisellsrealestate.net
508-380-1643


ustom Home Realty was created with the idea of offering a higher level of service, personal attention, and professionalism to our clients. CHR is committed to ensuring our clients are not just a number, but a member of our ever-growing family. We are proud to have created a reputation that is elevating the standards of real estate by providing exceptional service and advanced marketing techniques.
Simplify Home Realty
18 Maddie Way, Bellingham simplifyhomerealty.com
508-922-6571


Multiple Locations
sueranierisellsrealestate.net
508-380-1643

F or over 37 years, we have provided our clients with the personalized, quality service they deserve by listening to their wants, needs and concerns as they enter the real estate market. We treat our clients like family by being honest with them, walking them through every detail of the process, and helping them to make informed decisions in order to achieve their goals. We are right here for you and your family, so give us a call today.
Andrea Larson Ellsworth - RE/MAX Executive Realty
22 South St, Hopkinton facebook.com/andisoldmyhouse
508-498-1426















Definitive Accounting & Payroll
Multiple Locations
dftaccounting.com
508-478-2700

Definitive Accounting and Payroll was established in 2014 for professionals. We have more than 20 years of experience in business administration accounting, payroll, opening a corporation, LLC and DBA companies, insurance auditing, and all issues regarding business and personal financial administration. At Definitive Accounting and Payroll, whether your problem is big or small, we can solve it. We speak English, Portugues, and Spanish.
M Jackson Accounting & Bookkeeping LLC
mjacksonaccounting.com
508-213-8866


Piette Jewelers
429 Pulaski Blvd, Bellingham piettejewelers.com
508-876-0010

Milford Humane Society
289 West St, Miford milfordhumane.org
508-473-7008

Milford Humane Society is an allvolunteer, non-profit, no kill organization serving the greater Milford area. We provide shelter and veterinarian care to stray, unwanted and feral cats and kittens preparing for forever homes. Volunteers spend countless hours socializing feral and frightened animals. Success is measured by the number of cats rescued. Want to help cats? Stop by the shelter to meet other animal lovers and some great cats.
Baypath Humane Society
500 Legacy Farms N, Hopkinton baypathhumane.org
508-435-6938

amily owned and operated, Piette Jewelers has been proudly serving the jewelry needs of the Blackstone Valley community and beyond for over 65 years! For professional jewelry repairs, custom resets, overseas diamond buying, appraisals, engraving, watch repairs and a selection of the most unique jewelry and gifts from around the world, come visit Piette Jewelers. Our friendly sales staff is always ready to welcome you!
Trudel’s Auction Gallery
799 S Main St, Bellingham trudelsauction.com
877-966-3430


Trudel’s Auction Gallery
799 S Main St, Bellingham trudelsauction.com 877-966-3430


Step into the extraordinary world of Trudel’s Auction Gallery, where passion for antiques and collectibles takes center stage. Impeccable reputation spanning decades, discover a treasure trove of exquisite artifacts. Uncover timeless rare antiques, and curated treasures in an enchanting atmosphere. With unrivaled expertise and a reputation for excellence, Trudel’s is the premier destination for discerning collectors seeking a piece of history!
Gabriel’s Estate Sales & Auctioneers
638 Washington St, Norwood gabrielsauctions.com 781-769-1600


Charles River Bank
Multiple Locations
charlesriverbank.com
508-533-8661

We’re your neighbors, real people here to help you, your family, or your business access the best possible solutions for your financial needs. Whether you’re just starting out, figuring out how to pay for college, buying your first home, remodeling for your growing family, planning for retirement, or need cash management or financing for your growing business, your Charles River Bank team will help you make it happen.
Member FDIC * Member DIF
Milford Federal Bank
246 Main St, Milford MilfordFederal.com
508-634-2500







1 Nipmuc Dr, Mendon travelerbeautycompany.com
508-381-0068

Traveler Beauty Company is a beautiful full-service salon with a warm and welcoming environment, conveniently located on RT 16. TBC is an award-winning bridal hair and makeup company and we are excited to provide the same outstanding service and experience to clients looking for hair, nail, tanning and esthetic services. Our dedicated team provides nothing less than exceptional work by tailoring every service to accommodate the individual guest.
25 Taunton St, Plainville amorehairdesign.com 774-284-4872






190 Farm St, Bellingham asphaltengineering.net
508-541-8300

For Asphalt Engineering, this award was of the highest honor. Since the start of business in 2005, Asphalt Engineering has been active in the community: participating in local events, collecting donations for Fish and Loaves, sponsoring Hometown Hope, donating paving for the VFW Post 7272, providing scholarships to students, etc. They believe the blessing of success is truly granted to support the community in which they continue to grow.
Multiple Locations homefieldcu.com
508-839-5493


Lawrence Waste Services
49 Alder St, Medway
lawrencewasteservices.com
508-533-5200

Multiple Locations homefieldcu.com
508-839-5493

Aawrence Waste Services is a locally owned waste and recycling company that has been proudly serving our customers since 2006. We manage the waste and recycling needs of thousands of businesses throughout the greater Massachusetts and Rhode Island area. Our facility is located off Routes 495 and 109 in Medway, Massachusetts. We provide all our customers first class service, great equipment, and competitive rates.
72 Nickerson Rd, Ashland
gastaldowaste.com
508-315-7651

t Homefield Credit Union, we simplify our members’ lives, providing support and solutions to help achieve financial success. Our products and services are designed with member prosperity in mind. Founded in 1966, we are a community-based credit union open to all who live, work, or attend school in Worcester and Middlesex counties. Come experience Banking with a Homefield Advantage!
22 South St, Hopkinton websterfirst.com
508-671-5185







Treating the whole person, not just the teeth and gums.. This philosophy is alive and well in everything we do at the dentist’s office of David A. Goodman, DMD, and Alan C. Ko, DMD, Advanced Cosmetic & Prosthetic Dentistry. This approach to dental care reflects a foundation first set by Dr. Carl DiGregorio in 1968. When Dr. Goodman joined the practice in 1984, he built upon Dr. DiGregorio’s vision to give back to Milford and the wider area of southeastern Massachusetts through dentistry. Today, this legacy lives on in Drs Alan Ko, Brittany Bressler, and Saeed Kashefi. 192 West Street, Milford, MA 01757 (508)478-3800 goodmanko.com



Flood Fire Pro
852 Upper Union St, Franklin floodfirepro.com 800-446-3776

Flood Fire Pro Inc. is a family orientated, full-service disaster restoration company located in Franklin, MA. Respectfully restoring homes and business in all of Massachusetts and Rhode Island for over 30 years. With master designations in water, fire, mold, textile cleaning, and certifications in asbestos and lead removal, trauma-scene cleanup and infectious disease control. “Protecting your most important assets family, health, and home.”
Craftech Restoration
1 Walker Dr, Upton craftechrestoration.com 508-529-4505


The Moonlight Chef LLC
TheMoonlightChef.net
617-548-8873
I found my love for food and cooking at a very young age. While watching my mother and grandmother cook and entertain, I realized that the kitchen, with all its wonders, was where I belonged. I bring my passion and love for food to your table. Believing in the idea that good food can be simple, elegant, fun, exciting, comforting, and delicious. Cooking is a lifelong love. It is an extension of my personality, family traditions, and nurturing nature.
JK Catering & Events
JKCateringAndEvents.com
508-523-5569


Trudel’s Auction Gallery
799 S Main St, Bellingham trudelsauction.com 877-966-3430

Trudel’s Auction Gallery is more than just an Estate Sale Service— We’re your trusted partner during a significant life transition. Our knowledgeable team is here to support you, providing guidance and reassurance with the entire process. Extensive network of buyers/collectors ensures that your belongings receive the attention they deserve. We understand that every estate is unique and we tailor our services to meet your specific needs and goals!
Best Rate Cleanouts & Estate Sales
260 Main St, Milford bestratecleanouts.com 774-287-0300


Flowers by Danielle
194 West St, Milford flowersbydaniellemilfordma.com 774-448-0083


Flowers by Danielle a full service florist and gift shop. Offering same day delivery and specializing in flower arrangements for all occasions: special events, funerals, flower arranging classes, gift boxes and more! With over 20 years experience and a passion for designing, I will provide my customers with exceptional service, high quality fresh flowers and beautiful designs sure to put a smile on the recipient’s face!
Luna’s Flower Shop
83 Main St, Medway lunasflowershop.com 508-321-1018




Engineered Cannabis Specific Cultivation Facility & Process Remediation


CULTIVATION PROCESS & FACILITY CONTAMINATION MAPPING
Canna Klean thoroughly scans and investigates every square inch of your cultivation facility. Working side by side with 3rd party non-bias industrial hygienists we get to the source and underlying root cause of any cannabis facility contamination. We follow strict protocols to eliminate all threats to your cannabis company’s bottom line.


24/7 DISASTER RESPONSE & MANAGEMENT, AND INSURANCE CLAIM SPECIALISTS
Canna Klean & Remediation is available 24/7 to assist you with your cannabis facility disaster needs. Disasters happen when you least expect them to. Pipes burst, sewers back up, sprinkler systems get set off, soot and fire damage occur, generators fail, and HVAC systems fail.

Consigli Ruggerio Funeral Home
46 Water St, Milford
consigliruggeriofuneralhome.com
508-473-0513

F or over 75 years, family-owned Consigli Ruggerio Funeral Home has served the Milford community, providing personal service to families of all denominations. As a full-service funeral home, we can assist with arrangements for virtually any type of funeral. For peace of mind, we also specialize in pre-planning for your funeral. We designed and decorated our funeral home to have the appearance of a comfortable welcoming home.
Chesmore Funeral Home
Multiple Locations
ChesmoreFuneralHome.com
508-429-2391


Hopedale Technologies
258 Main St, Milford
hopedaletech.com
508-478-6010

Whether you are a home user or a small business, our mission is to deliver quality products, help you use technology efficiently and provide great services by partnering with solid providers. In addition to computer sales and service, Hopedale Technologies offers managed services including VOIP cloud phone systems, cyber-security, backup and endpoint protection.
Nerds To Go
Multiple Locations
nerdstogo.com
508-440-5025


Murphy Insurance Agency
133 Milford St, Medway dfmurphy.com
800-222-8711

Murphy Insurance offers insurance for auto, business, home, condo, renters, motorcycle, boat, life, disability, and more. We provide the protection you’ll need in a crisis and help you balance price and protection for maximum value. With 6 locations and 70 team members, we’re small enough to know you... large enough to serve you. Contact us to discuss your needs, and get a competitive review and coverage quote.
Gaudette Insurance Agency
Multiple Locations gaudette-insurance.com 508-234-6333


Fieldstone Veneer
49 1/2 Sumner St, Milford fieldstoneveneer.com 844-983-6337

Premium Natural Stone Veneer from Fieldstone Veneer Inc. is not only the finest veneer on market, but also has been selected from New England quarries/farms to provide dramatic texture and beauty to your project. Our products are available for architects, designers, builders, contractors and homeowners and can be used on stone siding, fireplaces, chimneys, foundations, interior-exterior walls and columns, indoor-outdoor kitchen, and much more.
Antron Engineering & Machine
170 Mechanic St, Bellingham antroneng.com 508-966-2803



Baystate Marketing
baystatemarketing.com
508-488-9043

Baystate Marketing is a digital agency specializing in enhancing your online presence. Our expert team offers robust search engine optimization, compelling website design, and effective social media management. We also excel in PPC and Google Ads campaigns, ensuring high visibility and traffic for your brand. Partner with us to achieve your digital marketing goals and drive meaningful engagement.
50 Walton St, Attleboro stickerprint.com
508-570-8956


Gallo Moving & Storage
120 Quarry Dr, Milford
gallomoving.com
508-422-4400

Ackerman Monument
2234 Washington St, Holliston ackermanmonument.com
508-429-5465

Aallo Moving is a full service residential and commercial mover. We offer storage in our 70,000-square-foot warehouse in Milford, MA. Our residential services include packing, crating, home staging and storage. We do local, interstate and international moves. Our commercial services includes moving offices, warehouses and labs. We support local non-profits including Claflin Hill, New Hope, Just Because, Milford Rotary, Milford Lions and Project Smile.
Motuzas Automotive & U-Haul
162 Milford St, Upton
motuzasauto.com
508-529-2450


ckerman Monument is a family owned and operated company servicing the Holliston area and the many surrounding communities for over 70 years. We help provide both at-need or pre-need services for families with monuments, lettering, markers, cleanings and repairs, along with all types of cemetery work. Our experience, craftsmanship, service and reputation has led us to be among the leaders in the industry.
629 South St, Wrentham TributeInStone.com
508-384-5826


Sweet Inspirations
19 Central St, Milford
sweetinspirationsmilford.com
508-205-7904

We are a non-profit, inclusive, retail candy and specialty gift shop that provides vocational and employment opportunities for individuals with intellectual and developmental disabilities. Inspired and managed by the Aaron Zenus Foundation, Sweet Inspirations provides meaningful employment and purpose to those we serve, and delivers on the Foundation mission of providing a path to achieve independence, social growth, and community integration.
Franklin Food Pantry
341 W Central St, Franklin franklinfoodpantry.org
508-528-3115












Hopedale Technologies
258 Main St, Milford hopedaletech.com
508-478-6010

Whether you are a home user or a small business, our mission is to deliver quality products, help you use technology efficiently and provide great services by partnering with solid providers. In addition to computer sales and service, Hopedale Technologies offers managed services including VOIP cloud phone systems, cyber-security, backup and endpoint protection.
Minuteman Press
231 E Main St, Milford ma202.minuteman.com
508-484-0004




PAWS Bed & Biscuit
97 Millville Rd, Mendon pawsbedandbiscuit.com 508-478-6390

PAWS Bed & Biscuit is your premier doggie daycare destination! Awarded best of the best year after year. We welcome all breeds and sizes, and our friendly staff can accommodate dogs of all ages and levels of activity. Our facility is located next to our home and designed with your furry kid in mind.
Fluxpack LLC
102 Adams St, Medfield fluxpackdogs.com 774-408-5124







































































The Bark Ark and Meow Too
32 Hastings St, Mendon thebarkarkandmeowtoo.com
508-473-4744

The Bark Ark and Meow Too is a premier pet grooming establishment located in Mendon, MA, that has been in business for over 50 years. We are a small family owned and managed company. Our mission is to look after your pet’s complete comfort, health and well-being during the entire pet grooming process as if they were our own. We offer professional grooming services at competitive prices. We always welcome new clients to join our furry family.
PAWS Bed & Biscuit
97 Millville Rd, Mendon pawsbedandbiscuit.com
508-478-6390


The Henry Studio
358 Mill St, Holliston thehenrystudio.com
508-429-2120

RPAWS Bed & Biscuit
97 Millville Rd, Mendon pawsbedandbiscuit.com
508-478-6390

We love your furry kid and take a caring, well rounded approach to training and behavior modification. Our Canine Foundation Levels allow you to choose from: basic, intermediate and advanced levels of training, along with our most popular Doggie Day School Program. Simply look at what each program offers and together we can decide what’s best for you and your furry kid.
In-Line K9 Training
160 Worcester-Providence Turnpike, Sutton inlinek9training.com 774-708-2702


ich has been photographing professionally for over 34 years and has captured countless weddings, portraits and events. Rich’s portraits are known for being natural, casual and candid. Our goal is to make your photo session easy and fun. Our studio is right on the border of Hopkinton and Holliston on a gorgeous private, wooded lot. Our outdoor setting looks beautiful any time of year!
Ashley Grace Photography
ashleygracephotography.net
774-253-8203


Grand View
6 Nipmuc Dr, Mendon grand-view.com
508-422-1000

Nestled in a quiet cove on the scenic shores of Lake Nipmuc, Grand View provides a stunning backdrop to create lasting memories. Our charming New England setting, with nine acres of landscaped grounds and manicured gardens, offers panoramic waterfront views from every vista as well as a small private beach and fire pit. We cannot wait to host you at our spectacular venue!
Lake Pearl Wrentham
299 Creek St, Wrentham lakepearl.com
508-384-3003



Jamie Oil and Propane Company
171 Main St, Ashland jamieoil.com
508-231-1400

Jamie Oil and Propane is an awardwinning heating, oil, and propane delivery and HVAC company that provides superior service whether you’re dealing with our friendly and knowledgeable office staff, courteous delivery drivers, or experienced HVAC technicians. We strive to provide the best service with the local touch so many customers have come to appreciate.
Inspirations
19 Central St, Milford sweetinspirationsmilford.com 508-205-7904


Marchand Environmental
Multiple Locations marchandenvironmental.com 508-962-4887

Marchand Environmental provides septic services, land clearing, demolition, dumpster rentals, and porta potty services in Massachusetts and Rhode Island. Marchand Environmental’s porta potty service includes regular, handicap and restroom trailers as well as shower units.
United Site Services, Inc.
118 Flanders Rd, Westborough unitedsiteservices.com 800-864-5387




New England Pressure Cleaning
NEPressureCleaning.com
508-474-9222

At New England Pressure Cleaning, we can handle all of your pressure cleaning needs. We have the equipment and expertise to tackle any commercial, residential, industrial or fleet pressure cleaning job. Our pressure cleaning fleet is equipped with soft-wash systems, and hot and cold pressure washing units to tackle any exterior cleaning service while providing cost-effective, damage-free results that are 100% satisfaction guaranteed.
AJ Pressure Washing Pro
2 Nolan Ave, Milford
Find us on Facebook
508-398-4787

Medway Oil & Propane Co., Inc
37 Broad St, Medway medwayoilpropane.com
508-533-6561


MFlood Fire Pro
852 Upper Union St, Franklin
floodfirepro.com
800-446-3776

Flood Fire Pro Inc. is a family orientated, full-service disaster restoration company located in Franklin, MA. Respectfully restoring homes and business in all of Massachusetts and Rhode Island for over 30 years. With master designations in water, fire, mold, textile cleaning, and certifications in asbestos and lead removal, trauma-scene cleanup and infectious disease control. “Protecting your most important assets family, health, and home.”
Craftech Restoration
1 Walker Dr, Upton
craftechrestoration.com
508-529-4505

edway Oil & Propane is a fullservice propane company that has been providing propane service since 1977. We have our own in-house service technicians that can help with your routine service and provide 24/7 emergency service. We provide propane installations for all kinds of propane uses. Propane is great for heat, hot water, fireplace, cooking, pool heat, generators and more! Medway Oil & Propane can help with all of your propane needs.
Eastern Propane
Multiple Locations eastern.com
508-541-4111


97 Millville Rd, Mendon
pawsbedandbiscuit.com 508-478-6390 W

e love to hear from you! Your pet’s happiness and your satisfaction are very important to us! Over 4,000 dogs cared for, 20 years in business, 15,000 dog treats given, and one of a kind service.

Pace Auto Service
34 Providence Ln, Whitinsville paceautoservice.com
508-234-9800



Gallo Moving & Storage
120 Quarry Dr, Milford gallomoving.com
508-422-4400

Gallo Moving is a full service residential and commercial mover. We offer storage in our 70,000-square-foot warehouse in Milford, MA. Our residential services include packing, crating, home staging and storage. We do local, interstate and international moves. Our commercial services includes moving offices, warehouses and labs. We support local non-profits including Claflin Hill, New Hope, Just Because, Milford Rotary, Milford Lions and Project Smile.
MI-Box Southern MA
20 High St, Plainville getmibox.com 774-719-7367


Brass Rose Tattoo
12 Beach St, Milford
brassrosetattoo.com
508-381-3483

Plus Tailors & Cleaners
189 Hartford Ave, Bellingham Find us on Facebook
508-966-1800

Established by Kane Rogers in 2014, Brass Rose Tattoo is a licensed shop in the heart of Milford. We have five talented artists who specialize in a variety of styles, especially black and grey. Brass Rose is proud to provide a friendly atmosphere and immaculate shop. Stop by sometime and meet the artists, Kane, Roni, Berto, David and Jade. Consultations can be set up by calling or emailing the shop’s Facebook page. We look forward to seeing you!
Ghost Town Tattoo And Piercing
15 N Main St, Bellingham
781-658-3978

veryone is always looking for a great dry cleaner and/or tailor. We’re proud to introduce you to the greatest one around— A Plus Tailors & Cleaners in Bellingham! We offer fast, quality service and unbelievable customer service, so stop staring at that pile of clothes that need dry cleaning or repairs. Take them to A Plus Tailors & Cleaners!
63 Main St, Hopkinton hillerscleaners.com
508-435-3880


Charles River Bank
Multiple Locations
charlesriverbank.com
508-533-8661


At Charles River Bank, we understand that your everyday banking is just one aspect of your financial life. You also have goals for the future— and for helping and protecting those you love. That’s why we offer a wealth of financial planning solutions, along with trusted guidance to help you and those you care about live the life you want.
Homefield Credit Union
Multiple Locations
homefieldcu.com
508-839-5493


MIDDAYS9AM-2PM

Midday's With Marissa















The Henry Studio
358 Mill St, Holliston thehenrystudio.com 508-429-2120

Rich has been photographing professionally for over 34 years and has captured countless weddings, portraits and events. Rich’s portraits are known for being natural, casual and candid. Our goal is to make your photo session easy and fun. Our studio is right on the border of Hopkinton and Holliston on a gorgeous private, wooded lot. Our outdoor setting looks beautiful any time of year!
B. Remembered
276 Turnpike Rd, Westborough brememberedweddings.com 508-625-7142







MyFM MyFM Invite the Street Team to your next event Invite the Street Team to your next event
"WE BRING"
"WE BRING"
MUSIC • GAMES • GIVEAWAYS & FUN
SCAN TO RESERVE YOUR DATE
SCAN TO RESERVE YOUR DATE





For generations, family-owned Consigli Ruggerio Funeral Home has served the Milford community, providing personal service to families of all denominations. As a full-service funeral home, we can assist with arrangements for virtually any type of funeral. Whatever your wishes, we will assist you in seeing that they are respected to the fullest extent. We extend a heartfelt invitation to you and your family and friends to stop by and visit with us.
It is difficult enough to deal with the death of a loved one, without having to sift through the seemingly endless details surrounding the funeral arrangements. At a time like this, you need the caring, personal attention of someone who will guide you through the arrangements - someone who will see to it that all necessary steps are taken and every detail covered.
Ruggerio Funeral Home










Hours of Operation: Monday - Friday 8 a.m. to 8 p.m. Central Time








































































Bernat Antiques
89 Elmdale Rd, Uxbridge facebook.com/bernatantique
508-278-5525

Bernat Antiques is an antique store located in Uxbridge, Massachusetts, with three floors of antiques in a beautiful old stone mill. We carry everything from rustic tools and simple chests to signs, glassware, decor, some fancy stuff, and lots of furniture in all conditions. It’s a great place to come for antiques, vintage and unexpected finds.
Archer Girl
89 Elmdale Rd, Uxbridge archergirlshop.com
508-361-9692


Kali Rose Boutique
1 Privilege St, Woonsocket kaliroseboutique.com

We are a size-inclusive online boutique who strives to provide beautiful, quality products at affordable pricing to women all over the U.S. We’ve been in business for 5 years in December and employ just over 40 amazing team members. We have been fortunate enough to also give back to our local schools and outreach programs each year since we started and are so thankful for everyone who has shopped and supported our small business over the years!
Peregrin
1 Maple St, Mendon peregrinshop.com
508-257-1369


Love Your Shelf - Used Books & More
9 N Main St, Bellingham loveyourshelfusedbooks.square.site
508-657-0124

Love Your Shelf is a family owned, independent bookstore located in the plaza at Bellingham Commons. We are the go-to place for book lovers of all ages featuring gently used and new books, vintage and rare books, gifts, music, movies, puzzles and games. We have books for every age in every genre, and our stock is always changing. We offer e-gift cards and complimentary gift wrapping. Love Your Shelf has something for everyone!
Rubber Chicken Comics
15 N Main St, Bellingham rubberchickencomics.com
508-966-2210













We are a size-inclusive online boutique who strives to provide beautiful, quality products at a ordable pricing to women all over the U.S. We've been in business for 5 years in December and employ just over 40 amazing team members. We have been fortunate enough to also give back to our local schools and outreach programs each year since we started and are so thankful for everyone who has shopped and supported our small business over the years!



Ve’Lace Bridal
11 Mechanic St, Bellingham velacebridal.com
508-966-0091

Ve’Lace Bridal specializes in bridal attire including wedding dresses, bridesmaids, mother of the bride and groom, and flower girls. Specializing in accessories, alterations, and bridal gown cleaning and preservation. At Ve’Lace Bridal, we provide our brides and guests the ultimate bridal experience.
Ve’Lace Bridal is your one stop bridal shop! Hours are Mon and Tue 11-7pm, Wed and Thurs 12-8pm, Fri and Sat 9-5pm, and Sundays reserved for VIP bridal.
The White Belle Home
62 Main St, Upton Find us on Facebook 508-277-5667


Stardust Jewelers
12 Uxbridge Rd, Mendon stardustmendon.com
508-478-2312


Stardust is a trusted family jeweler since 1978. With high quality gemstones and diamonds set into precious metals such as platinum, gold, and silver, you’re sure to find the perfect piece of jewelry for yourself or that special someone. Stop by Stardust Jewelers in Mendon today to browse beautiful collections from around the world, or to have your existing jewelry appraised or repaired. Come to Stardust Mendon for a jeweler you can trust!
American Historic Coins & Collectibles
15 N Main St, Bellingham ahcoinco.com






























Caroline’s Cannabis
Multiple Locations
carolinescannabis.com
774-243-0323
Welcome cannabis enthusiasts!

Caroline’s Cannabis is the first woman-owned adult-use dispensary in Massachusetts and on the East Coast. We work hard to curate and offer the largest recreational cannabis menu in the state which includes flower, pre-rolls, concentrates, edibles, vape cartridges, tinctures, topicals, CBD and accessories that are all locally sourced. Visit our website to shop the full menu!
Green Choice Dispensary
114 Main St, Blackstone greenchoicedispensary.com
508-928-1255


Love Your Shelf - Used Books & More
9 N Main St, Bellingham loveyourshelfusedbooks.square.site
508-657-0124

LCaroline’s Cannabis
Multiple Locations
carolinescannabis.com
774-243-0323
Welcome cannabis enthusiasts!

Caroline’s Cannabis is the first woman-owned adult-use dispensary in Massachusetts and on the East Coast. We work hard to curate and offer the largest recreational cannabis menu in the state which includes flower, pre-rolls, concentrates, edibles, vape cartridges, tinctures, topicals, CBD and accessories that are all locally sourced. Visit our website to shop the full menu!
Green Choice Dispensary
114 Main St, Blackstone greenchoicedispensary.com
508-928-1255


ove Your Shelf is a family owned, independent bookstore located in the plaza at Bellingham Commons. We are the go-to place for book lovers of all ages featuring gently used and new books, vintage and rare books, gifts, music, movies, puzzles and games. We have books for every age in every genre, and our stock is always changing. We offer e-gift cards and complimentary gift wrapping. Love Your Shelf has something for everyone!
Mass Armament
95 Mechanic St, Bellingham massarmament.com
774-708-0087


Pegasus Collectibles
108 Mechanic St, Bellingham pegasusbrz.com
508-498-8715

Our collectibles stores offer an extensive selection of Funko products, sports cards, and memorabilia for collectors and enthusiasts. Our knowledgeable staff are passionate about collectibles and are always eager to help you find that special piece to add to your collection. From the latest Funko Pop! figures to rare sports cards and autographed memorabilia, we are your one-stop-shop for all your collectible needs.
The Blessing Barn Home Store
5 Hastings St, Mendon theblessingbarn.com
508-634-2276






Marshall’s Jewelers
191 Mechanic St, Bellingham marshallsjewelers.com
508-966-4477

Marshall’s Jewelers is our family’s almost 70-year-old fine jewelry store. Richard, a graduate gemologist, heads our sales staff and specializes in custom jewelry design and appraisals. His wife Ann manages our state-of-the-art design and restoration department, with two full-time goldsmiths on staff. Our passion is making one-of-a-kind, custom jewelry right in our store that can be loved for many generations.
Janine’s Jewelry Design
841 Washington St, Holliston janinedesign.com
508-306-1064


American Historic Coins & Collectibles
15 N Main St, Bellingham ahcoinco.com
508-657-0902

Marshall’s Jewelers
191 Mechanic St, Bellingham marshallsjewelers.com
508-966-4477

Marshall’s Jewelers is our family’s almost 70-year-old fine jewelry store. Richard, a graduate gemologist, heads our sales staff and specializes in custom jewelry design and appraisals. His wife Ann manages our state-of-the-art design and restoration department, with two full-time goldsmiths on staff. Our passion is making one-of-a-kind, custom jewelry right in our store that can be loved for many generations.
Piette Jewelers
429 Pulaski Blvd, Bellingham piettejewelers.com
508-876-0010

merican Historic Coins & Collectibles is family owned and operated. We specialize in the buying and selling of coins, silver and gold bullion, currency, jewelry and much more. In addition, we offer specialty appraisal services for estates, insurance, or personal knowledge. Visit us at www.ahcoinco.com to see how we can assist you in building wealth with physical gold, silver and investment grade numismatic coins and currencies.
Piette Jewelers
429 Pulaski Blvd, Bellingham piettejewelers.com
508-876-0010



Mass Armament
95 Mechanic St, Bellingham massarmament.com
774-708-0087

We at Mass Armament pride ourselves on being friendly, knowledgeable and precise. Whether you’re the seasoned firearm owner, a complete novice or are somewhere in between, we are here to help. Our inventory consists of new and used firearms, ammunition, and accessories for many different applications. We specialize in hard to find pre ban items, military surplus along with the interesting/eclectic. We are your local one stop gun shop!
Bob’s Gun & Archery Shop
144 Gore Rd, Webster Find us on Facebook
508-943-6309













Founded in 2018, located directly above Crystal Pool, Mass Armament is a hidden gem in Bellingham. We have everything you can imagine from new productions to “pre-ban” classics. We also have the things you need to be safe and secure from pepper spray, eye and ear protection to laser training and much more. Your one stop shop for all your firearms necessities.






Koopman Lumber & Hardware
Multiple Locations
koopmanlumber.com
508-234-4545

At Koopman, we begin each day with the mission of making life better for the customers and communities we serve. You’ve counted on us for over 80 years to help find the perfect solution for your building, renovation and home improvement needs— from framing lumber to kitchen cabinets, the perfect windows or the perfect paint color. Come visit us, and let’s see what we can do together.
Rocky’s Ace Hardware
98 Main St, Medway acehardware.com
508-321-1630


Julio’s Liquors
140 Turnpike Rd, Westborough juliosliquors.com
508-366-1942

Marshall’s Jewelers
191 Mechanic St, Bellingham marshallsjewelers.com
508-966-4477

Marshall’s Jewelers is our family’s almost 70-year-old fine jewelry store. Richard, a graduate gemologist, heads our sales staff and specializes in custom jewelry design and appraisals. His wife Ann manages our state-of-the-art design and restoration department, with two full-time goldsmiths on staff. Our passion is making one-of-a-kind, custom jewelry right in our store that can be loved for many generations.
Janine’s Jewelry Design
841 Washington St, Holliston janinedesign.com
508-306-1064

t Julio’s Liquors, we offer 20,000 square feet of spectacular shopping in downtown Westborough, Massachusetts. With a wide variety of fine wines, spirits, beer and tobacco, we also have many other unique items and tasting events that set us apart from the average liquor store. Julio’s Liquors, experience the difference.
Franklin Liquors
333 E Central St, Franklin franklinliquors.com
508-528-7338


UpFront Guitars and Music LLC
2 S Maple St, Bellingham upfrontguitars.com
508-657-1817


UpFront Guitars is a new and used guitar and amp shop specializing in a carefully chosen selection of guitars, ukes, mandos, amps and accessories (pedals, cables, straps, strings, pickups, power, boards, cases) including brands G&L, ESP, Heritage, Harmony, Godin, Takamine, Traynor, NUX, Earthquaker Devices, JAM, WalrusAudio, and Mono. We also provide setups and repairs and offer in-person lessons. We’re here to help you find your sound!
Nevermind Shop
1 Milford St, Upton nevermindshop.com
508-529-2525

We deliver the right tools to inform customers that you want their business!
• Radio advertising on air
• Online Station website advertising
• Live remotes & appearances on location
• Variety of content delivered on demand
• Custom promotions & contests
• Concerts & events calendars
• Streaming, banners & video

• Personalities, endorsements & voices
• Traffic, news & sports updates
• Community & charity tie-ins
• Events marketing, sampling & hospitality
• Email database campaigns
• Social media integration
• Supporting & improving our communities

Cody’s Creations
4 Main St, Medway codyscreations.com
508-399-1031

Cody’s Creations began online as an Etsy shop making custom collars, waterproof leashes, treat bags and bandanas. In 2017, Cody’s opened a physical location in Medway welcoming customers and their dogs. You can peruse a specially curated selection of high quality dog items including treats, chews, plush toys, interactive puzzles, grooming supplies and so much more, while having your dog fit for a collar that is made on premises.
Happy Tails Market
191 Mechanic St, Bellingham happytailsmarket.com
508-657-3397


Peregrin
1 Maple St, Mendon peregrinshop.com
508-257-1369
PPLACE TO BUY A UNIQUE GIFT

Kali Rose Boutique
1 Privilege St, Woonsocket kaliroseboutique.com

We are a size-inclusive online boutique who strives to provide beautiful, quality products at affordable pricing to women all over the U.S. We’ve been in business for 5 years in December and employ just over 40 amazing team members. We have been fortunate enough to also give back to our local schools and outreach programs each year since we started and are so thankful for everyone who has shopped and supported our small business over the years!
Love Your Shelf - Used Books & More
9 N Main St, Bellingham loveyourshelfusedbooks.square.site 508-657-0124




eregrin is an artisan home goods boutique located in Mendon, MA. Peregrin’s Gift Registry Program invites engaged couples in for a private shopping experience to build their registry and follows through with an easy online registry service. Start your married life with a new-to-you heirloom, lasting generations to come, while supporting both local and global communities. Set your registry apart from the rest with thoughtful pieces from Peregrin.
The White Belle Home
62 Main St, Upton
Find us on Facebook
508-277-5667














Toto-Stevie Nicks-Def Leppard-Rod Stewart-U2-The Police-Journey-Bon JoviTears for Fears-Elton John-Aerosmith-John Waite-Don Henley-Bee Gees-Eric Carmen-John Mellencamp-Pink Floyd-Boston-Cutting Crew-Pat Benatar-John Parr-Mathew Wilder-Fleetwood Mac-Queen-Eagles-Jimmy Buffet-Foreigner-The Cars-Guns n Roses-Huey Lewis-Hall & Oates-Rolling Stones-AND MORE
oto-Stevie Nicks-Def JoviTears Gees-Eric Carmen-John Crew-Pat Parr-Mathew Wilder-Fleetwood n Roses-Huey Lewis-Hall & Stones-AND








Crystal Pool and Spa
95 Mechanic St, Bellingham crystalpoolstore.com
508-966-1322

Crystal Pool Store offers a complete range of high quality above ground swimming pools, inground liners, pool and spa supplies, pool parts, pumps and filters, and seasonal pool opening and pool closing service. We serve clients in the greater Bellingham, Milford, Hopkinton, Franklin, MA, area and surrounding towns in Metro West. We carry the leading brands of automatic pool vacuum cleaners to keep your pool sparkling clean all season long.
Village Pool & Spa Inc.
117 Main St, Medway villagepool.net
774-507-0636


Caroline’s Cannabis
Multiple Locations
carolinescannabis.com
774-243-0323
Welcome cannabis enthusiasts!

Caroline’s Cannabis is the first woman-owned adult-use dispensary in Massachusetts and on the East Coast. We work hard to curate and offer the largest recreational cannabis menu in the state which includes flower, pre-rolls, concentrates, edibles, vape cartridges, tinctures, topicals, CBD and accessories that are all locally sourced. Visit our website to shop the full menu!
Kali Rose Boutique
1 Privilege St, Woonsocket kaliroseboutique.com

JAM Packed Thrift Store
4 Evergreen Ln, Hopedale Find us on Facebook 617-285-2784

Jam Packed Thrift Store in Hopedale, MA, is a treasure trove of unique finds. Discover a diverse array of pre-loved clothing, furniture, and home decor at unbeatable prices. Embrace sustainable shopping with every visit to this community favorite thrift store.

Pegasus Collectibles
108 Mechanic St, Bellingham pegasusbrz.com
508-498-8715


Caroline’s Cannabis
Multiple Locations
carolinescannabis.com
774-243-0323
Welcome cannabis enthusiasts!

Caroline’s Cannabis is the first woman-owned adult-use dispensary in Massachusetts and on the East Coast. We work hard to curate and offer the largest recreational cannabis menu in the state which includes flower, pre-rolls, concentrates, edibles, vape cartridges, tinctures, topicals, CBD and accessories that are all locally sourced. Visit our website to shop the full menu!
Green Choice Dispensary
114 Main St, Blackstone greenchoicedispensary.com
508-928-1255

















Love Your Shelf - Used Books & More
9 N Main St, Bellingham loveyourshelfusedbooks.square.site 508-657-0124

Love Your Shelf is a family owned, independent bookstore located in the plaza at Bellingham Commons. We are the go-to place for book lovers of all ages featuring gently used and new books, vintage and rare books, gifts, music, movies, puzzles and games. We have books for every age in every genre, and our stock is always changing. We offer e-gift cards and complimentary gift wrapping. Love Your Shelf has something for everyone!
The Blessing Barn Home Store
5 Hastings St, Mendon theblessingbarn.com 508-634-2276


Kali Rose Boutique
1 Privilege St, Woonsocket kaliroseboutique.com

We are a size-inclusive online boutique who strives to provide beautiful, quality products at affordable pricing to women all over the U.S. We’ve been in business for 5 years in December and employ just over 40 amazing team members. We have been fortunate enough to also give back to our local schools and outreach programs each year since we started and are so thankful for everyone who has shopped and supported our small business over the years!
Rose’s Corner
90 Main St, Milford rosescorner.fashion 508-473-4920


A Touch Of Class Formalwear
159 Main St, Milford atocformalwear.com 774-276-2285

Discover elegance at A Touch of Class Formalwear in Milford, MA, where style meets sophistication. With a curated selection of exquisite formal attire for weddings, proms, and special occasions, they ensure every customer finds the perfect fit. From timeless tuxedos to fashionable suits, our expert staff provides personalized service, making every visit memorable. Embrace luxury and refinement at A Touch of Class Formalwear.
Spallone & Son
90 Main St, Milford spalloneandson.com 508-473-4920






D&M Auto Parts was originally established in 1994 and is proudly familyowned and operated. With multiple locations in Massachusetts and Connecticut, we pride ourselves on product availability and fast, reliable customer service. Our company has grown to be a trusted and dependable one-stop shop for all your automotive needs. Whether it’s a do-it-yourself or professional fix, do it with our team of dedicated professionals ready to serve you! For more store information and hours, please visit our website: www.dmautopartsinc.com
















West Street Autobody
69 West St, Milford weststreetautobody.com
508-473-4050

At West Street Autobody, our goal is to provide the perfect experience when it comes to vehicle collision repairs. We are a family owned business and we take pride in our work. We are here to make sure your vehicle is repaired right.

Imperial Cars
8-18 Uxbridge Rd, Mendon imperialcars.com 800-526-2886
AMilford Nissan Collision Center
Multiple Locations
milfordnissancollisioncenter.com
508-473-8350


Milford Nissan
Multiple Locations
milfordnissan.com
508-422-8000

Milford Nissan is a multiple year winner of the Nissan Award of Excellence. We are located on Route 16 in Milford and are a full service dealership with new Nissan vehicle sales and leasing, Certified Pre-Owned Nissan vehicles, Nissan commercial trucks, service, genuine Nissan parts and a Nissan Certified collision center. We are family owned and operated and have an amazing staff of long term employees. Come see us for a great experience!
Empire Automotive Group
439 Washington St, Holliston empireautomotivema.com
508-422-7322

t Imperial Cars, we are committed to delivering an exceptional customer experience whether you’re in the market for a new or used car, truck or SUV, commercial vehicle for your business, or service and parts to maintain your vehicle. We have 7 brands and stock over 2,000 vehicles at our four dealerships in Mendon and Milford. Our service departments are staffed by factory-trained technicians, and we offer express oil changes.
Milford Nissan
Multiple Locations milfordnissan.com
508-422-8000


Carquest Auto Parts - D & M AUTO - MILFORD 124 Prospect St, Milford carquest.com
508-473-1185


D& M Auto Parts was originally established in 1994 and is proudly family-owned and operated. With multiple locations in Massachusetts and Connecticut, we pride ourselves on product availability and fast, reliable customer service. Our company has grown to be a trusted and dependable one-stop shop for all your automotive needs. Whether it’s a do-it-yourself or professional fix, do it with our team of dedicated professionals ready to serve you!
Interstate Battery
235 E Main St, Milford interstatebatteries.com 781-232-5095

















Ray’s Automotive
232 West St, Milford
myfm.bigdealsmedia.net/advertiser/18268/ rays-automotive 508-422-9711

We are so much more than a service center! Here at Ray’s, we love providing the best service possible, but we also love doing our part to make our community a better place. Whether it’s sponsoring the Local Lowdown, which helps local musicians promote their gigs on MyFM, to charity raffles and concerts, we love helping make Milford the wonderful community it is!
Pace Auto Service
34 Providence Ln, Whitinsville paceautoservice.com 508-234-9800
















































Franklin Car Wash
349 E Central St, Franklin thefranklincarwash.com
508-520-0075

The Franklin Car Wash has been proudly serving the MetroWest area since 1987. We aim to provide exceptional car washing and detailing services at affordable prices. Whatever type of cleaning your automobile may need, we provide efficient service with a personal touch.

JT’s Diesel Performance
28 Hastings St, Mendon facebook.com/jtsdieselperformance 774-627-8231
JBrad’s Auto Reconditioning
300 Commerce Dr, Northbridge bradsautoreconditioning.com 508-901-0635


Franklin Car Wash
349 E Central St, Franklin thefranklincarwash.com
508-520-0075

The Franklin Car Wash has been proudly serving the MetroWest area since 1987. We aim to provide exceptional car washing and detailing services at affordable prices. Whatever type of cleaning your automobile may need, we provide efficient service with a personal touch.
Imperial Cars
8-18 Uxbridge Rd, Mendon imperialcars.com 800-526-2886


T’s Diesel Performance is a full service diesel mechanic shop that specializes in diesel repair and performance along with fleet maintenance and heavy equipment repair. We are located in the small town of Mendon right off of Route 16 in the Hastings street plaza. Stop by and check us out.
MGM Auto
14 Main St, Upton facebook.com/MGMAuto999 508-529-1401


Imperial Cars
8-18 Uxbridge Rd, Mendon imperialcars.com 800-526-2886

Imperial Wash and Detail offers a variety of exterior washes as well as detail services. You can have your vehicle washed in our state-of-the-art car wash with the ability to customize your wash with the services your vehicle needs. We also offer a variety of detailing services that range from 30 minute express details while you wait to full vehicles services. Visit our website for current promotions or call us to schedule your detail.
Car Wash
349 E Central St, Franklin thefranklincarwash.com 508-520-0075














With over 15 years of experience, Brad’s Auto Reconditioning offers our clients the best detailing experience for all your vehicle needs! We specialize in paint correction, ceramic coatings, paint protection film, window tint, and vinyl wraps. Our clients come from all over New England for our top of the line Self Healing Coatings! Our Dry to Touch Rust Protection undercoating is a premium matte black undercoating that lasts up to 10 years! This undercoating protects your undercarriage from the harsh New England elements our vehicles are exposed too.

Ray’s Automotive
232 West St, Milford
myfm.bigdealsmedia.net/advertiser/18268/ rays-automotive
508-422-9711

We offer one of the most thorough state inspections in the area from 8 am - 5:30 pm Monday through Friday and 8 am - 2:30 pm Saturdays! Our certified technicians ensure vehicles meet all safety and emissions standards with thorough inspections and prompt service, ensuring peace of mind for drivers in the community.
Millville Service
276 Main St, Millville millvilleservice.com 508-883-7377


Milford Tire Products Inc
244 S Main St, Hopedale Find us on Facebook
508-473-1600

Millville Service
276 Main St, Millville millvilleservice.com/ 508-883-7377

Ooted best tire store by our loyal and new customers. Milford Tire Products has been family owned since 1934 and has served the local area for four generations. We’re your one-stop shop for all your tire and auto repair needs. For our full range of services, check out our ad. We always have our customers’ best interests in mind, as well as their safety. We know our customers are also our friends and neighbors in our community.
Ray’s Automotive
232 West St, Milford
myfm.bigdealsmedia.net/advertiser/18268/rays-automotive
508-422-9711

ur growth and success over the years have been possible thanks to our dedicated customers who value our unwavering commitment to honest and thorough automotive services. We firmly believe that our customers’ satisfaction is paramount, and we won’t rest until they leave our shop content with our work. Come on in to experience the finest auto repair services provided by our skilled auto professionals. We eagerly await your visit!
Ray’s Automotive
232 West St, Milford
myfm.bigdealsmedia.net/advertiser/18268/rays-automotive 508-422-9711


Auto Go
7 Charles River Rd, Milford autogoservice.com 508-473-0353


Auto Go, Inc. is a family-owned and operated auto repair shop serving Milford, MA since 1985. However, while we’re a local, family business, we’re far from a small-scale garage. Our state-of-the-art, full-service automotive repair facility is AAA approved, and our technicians are ASE certified and equipped to work on all types of vehicles, including heavy trucks and equipment. AAA discounts apply to all members.
West Street Autobody
69 West St, Milford Find Us on Facebook 508-473-4050







Ray’s Automotive
232 West St, Milford
myfm.bigdealsmedia.net/advertiser/18268/ rays-automotive
508-422-9711

We do what it takes to get you back on the road feeling safe and satisfied! With over 20 years of helping our community, we pride ourselves on having the best customer service in the industry!
Auto Go
7 Charles River Rd, Milford autogoservice.com
508-473-0353








495 Rental Center 64, 65
A Plus Tailors & Cleaners 152
A Touch Of Class Formalwear 176
Acapulcos Mexican Family Restaurant & Cantina Milford 42, 44, 48
Accent Limousine 17
Ackerman Monument 142
ADC Septic 84
Adviniacare Northbridge 16, 116, 120, 124
AJ Pressure Washing Pro 150
Al’s Rubbish and Container Service 72
Alicante Restaurant & Lounge 50
All-Temp Systems Mechanical, LLC 54, 69
Allegra Print 6
American Climbers 86, 87
American Historic Coins & Collectibles 162, 166
Amore Hair Design 135
Andrea Larson EllsworthRE/MAX Executive Realty 130
Angel’s Garden Center 64
Antron Engineering & Machine 140
Archer Girl 160
Arena Meat Market 29, 45, 163
Ashley Grace Photography 146
Asphalt Engineering 68, 76, 136, Back Cover Auto Go 182, 186, 188
B
B & L Pools & Spas 80
B Remembered 154
The Bark Ark and Meow Too 146, 147
Basic Batch Donuts 36
Baypath Humane Society 134
Baystate Marketing 142
Bellingham Business Association 78
Bernat Antiques 10, 160, 163
Best Rate Cleanouts & Estate Sales 138
Birchlers Automotive 189
Bite Me Organic Mosquito Control 78
THE BLACK BOX 12, 16
The Black Harp Mobile Irish Pub 50
Blackhawk Pizza 45
Blackstone National Golf Club 14
Blackstone Valley Art Association 10
Blackstone Valley Chamber of Commerce 37
Blackstone Valley Family Physicians 120
Blackstone Valley Vocational 21
The Blessing Barn Home Store 164, 176
Blooming Hearts Roastery & Cafe 26, 28, 34, 38
Blue Square Pizza 45
Bob’s Gun & Archery Shop 166
Brad’s Auto Reconditioning 184, 185
Brass Rose Tattoo 152
Brian Crockett Counseling, LLC 120
Burns Law Office, P C 93, 94, 96
C
C & C Ice Cream Truck 30, 36, 40
C R Schmall Building & Remodeling LLC 58, 82
The Candy Cottage 163
Candy Under Cover 2 34
Canna Klean 139
Caroline’s Cannabis 164, 165, 172, 173, 174
Carolyn Rae & the Rumors 17
Carpet Lover Plus Inc 55, 58
Carquest Auto PartsD & M AUTO - MILFORD 177, 180
Carruth Capital LLC 128
Casey’s Cuts 102
CBJ Environmental 128, 129
Cedar Chiropractic & Sports 116
Century 21 The Real Estate Group 128
Charles River Bank 126, 128, 135, 152
Charron Tree Service 86
Chesmore Funeral Home 140
The Claflin Hill Music Performance Foundation, Inc 92
The Claflin Hill Symphony Orchestra 15, 16
Coachmen’s Lodge 44
Cody’s Creations 170
Coletta’s Furniture 76
Concierge Physical Therapy 122
Consigli and Brucato PC 94, 96
Consigli Ruggerio Funeral Home 140, 156, 157
Core Electrical Services LLC 62, 63
Cornell’s Irish Pub 41
The Corner Market Holliston 47, 48
Cornerstone at Milford Assisted
Living & Compass Memory Support 116, 117
Country Fitness 102
Craftech Restoration 138, 150
CraftRoots Brewing 12, 28
Creative Community Childcare 21
Crossroads Nutrition 42
Crystal Pool and Spa 70, 80, 174, 175
The Curry House 35, 46
Curtain Factory Outlet 88
Custom Home Realty 128, 130, 131
DD & T Pest and Termite Control, Inc 78, 79
Dacey’s Market & Deli 36, 62
Dairy Queen Grill & Chill Milford 31, 32, 38
Dairy Queen Grill & Chill of Bellingham 32, 36, 38, 39
Dana-Farber Brigham Cancer Center at Milford 118
Dean College 20
Definitive Accounting & Payroll 134, 144
Dellaria Salon 104
Dental Place Hopkinton 122
Depot Street Tavern 28
The Donut Stand 26, 36
Doubletree Hotel Boston Milford 16, 26, 29, 192, 193
Dr Goodman, Ko, Bressler & KashefiAdvanced Cosmetic & Prosthetic Dentistry 116, 118, 120, 122, 136
Dr Michael J Pfeffer & Associates 120
Duct Tape Wallet 10, 16, 17
Eastern Propane 133, 150
Elder Care Management 115
Elizabeth’s Bagels & More 26, 29
Empire Automotive Group 180
Ernest H Horn, Horn & O’Loughlin Law 96
ETS Equipment Rental 56, 57, 64
Every Bodies Massage 106
FFairfield Inn & Suites Boston Milford 16
Fairmount Fruit Farm Inc 37, 105
Family Karate Center 12, 106
Family Orthodontics 122
Fieldstone Veneer 108, 109, 140
Flood Fire Pro 74, 75, 138, 150, 151
Flowers by Danielle 138
Fluxpack LLC

KKali Rose Boutique 160, 161, 170, 174, 176
King Street Cafe 30, 32, 46
Knights Airport Limousine Services 17
Koopman Lumber & Hardware 54, 168
L
La Cantina Winery 51
Lake Pearl Wrentham 146
Landscape Services 66
Larry Joe’s New England Firepit 40
The Lash Lounge Milford Crossing 102
The Law Offices of James G DeGiacomo 94
Law Offices of Michael M Kaplan, P C 96
Lawrence Waste Services 88, 136
Legends Sports Bar & Grille
@ DoubleTree Milford 16, 26, 30
Lioce Properties Group 128
Little Critters Daycare & Preschool 20, 21
The Little Gym of Medway 15
live love BARRE 104
Lobisser & Ferreira Construction Corp 58, 90, 91
Love Your Shelf -
Used Books & More 68, 160, 164, 170, 176
Lovejoy Carpet Cleaning 54, 58
Luna’s Flower Shop 138
MM Jackson Accounting & Bookkeeping LLC 134
M Coelho Group 66, 67, 72
Marchand Environmental 52, 84, 85, 148, 149
Marshall’s Jewelers 83, 166, 168
Mass Armament 24, 164, 166, 167
Mass Renewables 84, 86
Master Roof Inc 64, 82, 84, 86
Mckeon Dance & Gymnastics 14
Medway Business Council 60
Medway Oil & Propane Co Inc 70, 71, 150
MetroWest Boston Visitors Bureau 21
MetroWest Medical Center 124
Metrowest Veterinary Associates 124
MGM Auto 184
MI-Box Southern MA 152
Mickey Cassidy’s 41
Milford Federal Bank 135
Milford Hardwood Floors Inc 58, 59
Milford Humane Society 134
Milford Nissan 180, 181
Milford Nissan Collision Center 180

Milford Regional Medical Center 12, 111, 118, 119, 124
Milford Regional Physician Group 120
Milford Tire Products Inc 186, 187
Millis Animal Hospital 124
Millville Service 186
Milton CAT 2, 3, 110
Mint Dental of Franklin 116
Minuteman Press 98, 144
Miracle-Ear 118
Mirick O’Connell 94, 96, 98
Modern Design & Build LLC 60, 76, 82, 84
Momentum Solar - MA Office 84
The Moonlight Chef LLC 50, 138
Motuzas Automotive & U-Haul 142
Muffin House Cafe 26, 34, 35, 44, 47
Murphy Insurance Agency 60, 140 N
NCK Bellingham 106
Nealon, Nealon & Click 94
Nelly’s Sandwich Shop 38, 47
Nerds To Go 140
Nevermind Shop 168
New England Cheer and Tumble Training Center 15, 17
New England Pressure Cleaning 150
New England Steak & Seafood 34, 38, 46, 48, 49, 51
Notturno Home Services 54, 81, 80
Nutriforia Nutrition 42
Oakwoods Landscape Construction Inc 53, 68
Oasis Patio @ Doubletree Boston-Milford 34, 44
OB Marble and Granite Inc 54, 60, 61
Oliva’s Market & Catering 32, 36, 45, 154
Oral Surgery Partners 122, 123 Out Post Farm 37
Outdoor Personia 76 P
Pace Auto Service 150, 182
Palmer Family Chiropractic 116
Pandolfi’s Fine Chocolates 34
Paradise BBQ and Catering 28, 40, 160
The Parlour At Chat Noir 106
Paul Flaherty Plumbing & Heating 80
Paula McSweeney, LICSW 120
PAWS Bed & Biscuit Cover, 144, 145, 146, 150, 158
Pegasus Collectibles 164, 174
Peregrin 160, 170, 176
Piette Jewelers 134, 166
PiNZ Bowl 14
Pirate’s Cove 34, 38, 40, 42, 46
PJ’s Bar & Grill 26, 27, 46
PJ’s Smoke ‘N’ Grill 32, 46
Platinum Physical Therapy 122
Pond Home 124, 125
Pool Pro & Spa 70
Purely You Aesthetic Boutique 107, 118
Putts & More Family Fun Center 14
Radiant Cleaning Services Inc 70
Ray’s Automotive 182, 183, 186, 188
Rectify Barbershop & The Beauty Alcove 106
ReMax Executive Realty- Chuck Joseph 130
Restaurant 45 26, 50
Restaurant 89 36, 38, 41
Rison Seamless Gutters 64
Rocky’s Ace Hardware 168
The Rome Restaurant 41, 48, 170
Rose’s Corner 176
Rosewood Restaurant 42
Royal Thermal View, Inc 88, 89
Rubber Chicken Comics 160
RxFitness and Health
(CrossFit Never Doubt) 102, 104
Ryan Family Amusements 12
SSally’s Alley 88
Salmon Senior Living: The Willows and Whitney Place at Medway 16, 114
Salone de Bella 102, 104, 107, 122
Sanford Nutrition Consulting 116
Scarlet Spa 107
Scott M Haynes Electrician Inc 62
Shawn’s Landscaping 72, 73
Shining Rock Golf Club 14
Simon’s Furniture 54, 64, 76
Simplify Home
































